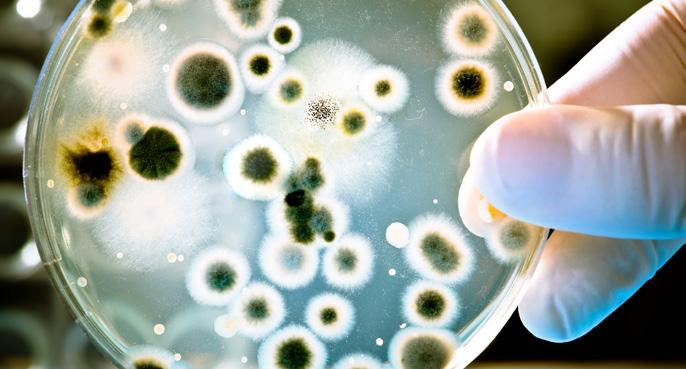

![]()







Inneholder både klorheksidin og fluor
Flux PRO Klorhexidin Skyll
0,12% Klorheksidin
0,2% NaF
0% Alkolhol

Smak av Coolmint
Flux PRO Klorhexidin inneholder både klorheksidin og fluor. Produktene er for kortidsbehandling eller etter anbefaling fra tannhelsepersonell. Som øvrige Flux produkter er de uten alkolhol og parabener. Utviklet i samarbeid med skandinavisk tannhelse.
Dosering:
Voksne og barn over 12 år: Brukes 1–2 ganger daglig i inntil to uker eller etter anbefaling fra tannhelsepersonell. Skyllen har en praktisk doseringspumpe som gir riktig dosering hver gang.
Flux PRO Klorhexidin Gel
0,12% Klorheksidin
1000 ppm F
0% Alkohol
Smak av Coolmint
Har du fluxet i dag?
2 Forbundsleder har ordet
6 Småstoff
10 Deling av passord i strid med reglene
14 Allergiske reaksjoner i tannhelseklinikken
16 Tannhelseteam bidrar sterkt til helseforskningen
20 Utførelse av sporeprøver på tannlegekontoret
22 Svake pensjonsordninger for tannhelsekretærene
Både leverandøren av det mest utbredte journalsystemet for tannklinikker og representanter for tannhelsesekretærene hevder at det pågår deling av passord ved norske tannklinikker.
Illustrasjonsfoto Foto: iStock
24 Parats medhjelpere i Høyesterett
26 EUs arbeidsmarkedsbyrå
28 Ferietid og ferieloven
32 Drømmer om å mekke Norges nye kampfly
36 Parat informerer
38 Spørsmål fra medlemmer
40 Kryssord, sudoku, anagram og på kryss og tvers
42 Leder i Parat


Utgis av: Tannhelsesekretærens
Forbund tilsluttet Parat
Tannhelsesekretærens Forbund, Lakkegata 23
Postboks 9029 Grønland 0133 OSLO
www.thsf.no www.parat.com
Besøksadresse: Lakkegata 23
Telefon: 21 01 36 00
Teleaks: 21 01 38 00
E-post: thsf@parat.com
Ansvarlig redaktør: Trygve Bergsland
Mobil: 905 85 639
E-post: trygve.bergsland@parat.com
Leder: Gerd Bang-Johansen
Mobil: 984 88 100
E-post: gerd.bang.johansen@parat.com
Forsidefoto: Unilabs. Avbildet Åse Nysæter.
Alle illustrasjonsbilder i bladet som ikke er kreditert er levert av iStock.
Redaksjonen avsluttet: 11.6.2018
Materiellfrist neste nr: 3.9.2018

Tannhelseteam bidrar sterkt til helseforskningen
Omfattende helseundersøkelser i befolkningen er kommet for å bli. Snart er en egen forskrift om helseundersøkelser i befolkningen på plass.
Det er viktig at rutinene for sterilisering i autoklaven er på plass på et tannlegekontor. I tillegg er mikrobiologisk kontroll av unitvannet nødvendig.
ISSN: 1504-5714
ISSN: 1890-9116 (online)
Layout: 07 Media, avd. Moss www.07.no
Telefon: 22 79 95 00
Trykk: Ålgård Offset AS www.a-o.no
Telefon: 51 61 15 00



Bezawit (9) bor i slummen i Etiopia. Hennes høyeste ønske er å gå på skole, men for at familien skal klare seg, er hun nødt til å arbeide store deler av dagen. Uten utdanning har Bezawit små sjanser til å komme seg ut av fattigdommen.
Bezawit (9) bor i slummen i Etiopia. Hennes høyeste ønske er å gå på skole, men for at familien skal klare seg, er hun nødt til å arbeide store deler av dagen. Uten utdanning har Bezawit små sjanser til å komme seg ut av fattigdommen.
Det er ikke lett å forstå hvordan hun har det. Men du har kanskje tenkt på hvordan hun burde hatt det? Tenkt at du vil hjelpe?
Det er ikke lett å forstå hvordan hun har det. Men du har kanskje tenkt på hvordan hun burde hatt det? Tenkt at du vil hjelpe?
Blir du Plan-fadder i dag, gir du barn som Bezawit en bedre framtid.
Blir du Plan-fadder i dag, gir du barn som Bezawit en bedre framtid.
Send SMS FADDER til 03123 www.plan-norge.no
Send SMS FADDER til 03123 www.plan-norge.no


Nå har vi startet forberedelsene til nytt landsmøte som avholdes 20. og 21 mars 2019 på Gardermoen. Der skal det velges leder, nestleder, sekretær og styremedlemmer. Valgkomiteen er allerede godt i gang med sitt viktige arbeid som skal presenteres på landsmøtet.
Jeg oppfordrer alle til å komme med forslag på kandidater som innehar den kompetansen et styre trenger for å videreføre ThsF arbeid med medlemmenes lønns og arbeidsvilkår, visjon og satsningsområder.
Prosessen i valgkomiteen vil holde fram til noen få uker før landsmøtet, og det er viktig at alle engasjerer seg og fortsetter å sende inn forslag på kandidater til valgkomiteen.
Tjenestepensjon i offentlig sektor

Endelig er ny offentlig tjenestepensjon vedtatt. Det har tatt mange år, og jeg er glad for at vi nå har kommet frem til et godt og forutsigbart resultat. Over 90 medlemmene har i en uravstemning sagt ja til en ny pensjonsordning.
Det betyr at pensjonsreformen i stor grad er fullført, og at hovedprinsippene er like i offentlig og privat sektor. Dette gjør at offentlige ansatte får samme fleksibilitet som i privat sektor, og
kan selv velge selv når de vil ta ut pensjonen. Det blir også lettere å veksle mellom å jobbe i privat og offentlig sektor. Med det nye systemet vil offentlig ansatte heller ikke tape på å bytte jobb til privat sektor mot slutten av karrieren, slik det er i dag.
Den nye pensjonsordningen innføres fra 2020 for ansatte som er født i 1963 og senere. Ansatte født før 1963 beholder dagens pensjonsordning. I tillegg innføres det en betinget tjenestepensjon for ansatte som ikke kvalifiserer til AFP.
Å få flere til å stå lenger i arbeid er hovedmålet, og det blir nå mulig å jobbe etter 62 år med fleksibelt uttak av AFP. Den nye ordningen gir pensjonsopptjening i alle år fram til 75 år, i motsetning til dagens ordning der offentlig ansatte ikke får noe igjen for å jobbe mer enn 30 år.
Ønsker alle våre tillitsvalgte og medlemmer en god sommer
Med vennlig hilsen
Gerd Bang-Johansen

I alt 19 leger har måttet tilbakebetale til sammen 13 millioner kroner for feilutbetalinger i 2015 og 2016, men ingen er straffet, og alle beholdt jobben. Samtidig har NAV de tre siste årene anmeldt mellom 1000 og 1500 personer for trygdesvindel – hvert år. I snitt dømmes rundt 900 personer hvert år for grovt bedrageri etter anmeldelser fra NAV. De aller fleste av dem har fått fengselsstraff, melder NRK.
I 2015 og 2016 kontrollerte legenes kontrollorgan Helfo til sammen 19 fastleger for bruk av taksten som er den største refusjonsutbetalingen fra Helfo til fastleger. Samtlige hadde uriktig takstbruk for beløp fra 150 000 opptil 1,3 millioner kroner. (NTB)
Helseindustrien har hatt en rekordvekst de siste tre årene, viser en rapport. Samlet ligger veksten på 4,5 milliarder kroner i året. Siden 2014 har næringen for alvor tatt av, viser rapporten fra Menon Economics, som er blitt presentert.
I 2016 vokste næringen med nesten 9 prosent, og i fjor anslås veksten å ligge på 9,5 prosent. For 2018 ligger prognosen på 8,8 prosents vekst. (NTB)


Det var en liten økning av utbrudd av smittsomme sykdommer i 2017, melder Folkehelseinstituttet. Underrapportering er fortsatt et problem. I 2017 ble det varslet 162 utbrudd med totalt 2320 rapporterte sykdomstilfeller. Dette er litt mer enn i 2016, men på samme nivå som årene før, heter det i Folkehelseinstituttets ferske rapport.
Ved 36 av utbruddene var det mistanke om smitte fra næringsmidler. Over 60 prosent av alle utbrudd ble varslet fra helseinstitusjoner. (NTB)
Norsk Tannvern inviterer til samarbeid for sosial likhet i tannhelse.
Nettstedet tannvern.no er omarbeidet til et digitalt senter for informasjon. Alt materiell kan lastes ned uten kostnad.
Ifølge Forbrukerrådets tannlegeoversikt hvakostertannlegen.no er Østfold det billigste fylket i landet å gå til tannlegen. I Østfold koster en time hos tannlegen i gjennomsnitt 788 kroner. Landets dyreste fylke er Finnmark med 1014 kroner i snitt.

Prisene inkluderer kontroll av tenner, tannkjøtt og munnhulen, to røntgenbilder, enkel tannrens, hygienetillegg og alle nødvendige kostnader knyttet til behandlingen.

Bruk tannvern.no for nedlasting av materiell og faglig oppdatering
Helfo vil gå fra å ha 22 kontorsteder til 6, fastslår regjeringen. Det rammer 165 av Helfos ansatte.
Regjeringen har besluttet at 16 kontorer med rundt 165 Helfo-ansatte skal nedlegges. Det vil ramme kontorer i Oslo, Bergen, Kristiansand, Voss, Eidsvoll, Kongsberg, Risør, Harstad, Gloppen, Vågå, Verdal, Nærøy, Lenvik, Beiarn, Orkdal og Brumunddal.
Helfo, som er Helsedirektoratets ytre etat, varslet i 2017 behov for en ny kontorstruktur for å oppnå effektiv ressursutnyttelse. Økt bruk av selvbetjening og automatisering og færre enkle, manuelle arbeidsoppgaver har redusert behovet for ansatte. (NTB)




Ni dollar per person årlig. Det er alt det ville koste å gi kvinner i fattige land full tilgang til moderne prevensjon og gravide helsehjelpen de trenger.
Likevel er det hvert år 200 millioner kvinner i utviklingsland som ikke bruker moderne prevensjon, selv om de ønsker å unngå å bli gravide. 45 millioner kvinner har ingen eller dårlig fødsels og barselomsorg. Tallene kommer fram i en stor rapport som er publisert i tidsskriftet The Lancet. (NTB)
Over 90 prosent av befolkningen har tillit til at tannleger i Norge er faglig kvalifiserte til å gi den behandlingen man har behov for. Faglig dyktighet er også det flest legger vekt på ved valg av tannlege, ifølge resultatene fra årets Helsepolitiske barometer.
59 prosent lister det blant de viktigste kriteriene, mens 42 prosent velger tannlege i nærheten av der de bor, og 31 prosent legger mest vekt på pris. Hele 59 prosent etterlyser mer offentlig støtte til voksne personers tannhelsetjenester, og det er meget bred enighet (80 prosent) om at offentlig støtte til tannbehandling bør forbeholdes tannbehandling utført i Norge.
Kilde: Tannlegeforeningen.no


Langt flere norske barn og unge får tannregulering enn barn i skandinaviske naboland. Ifølge Helsedirektoratet har det norske finansieringssystemet trolig skylda.
Mellom 2008 og 2017 utbetalte Helfo omtrent 5,5 milliarder kroner i støtte til kjeveortopedisk behandling i Norge. Årlig utbetales det rundt 500 millioner i støtte til behandling, og 30 000 norske barn og ungdommer begynner med tannregulering. Det utgjør 33 prosent av hvert årskull. – Problemet med stønadsordninger er at de har en tendens til å virke behandlingsdrivende, sier seniorrådgiver i Helsedirektoratet Per Lüdemann til NRK.
Datatilsynet har bestemt at fastleger skal kunne reservere seg mot at pasienter vurderer dem på nett. Forbrukerrådet har en annen oppfatning. På Legelisten.no, som ble lansert i mai 2012, kan folk legge ut vurderinger av leger, tannleger og spesialister.
Fagdirektør Anne Kristin Vie i Forbrukerrådet mener nettsiden er et viktig supplement til Helsenorge. no, hvor man velger fastlege. Hun håper derfor vedtaket Datatilsynet gjorde før jul, ikke blir stående. Vie beskriver Datatilsynets beslutning som bekymringsfull og mener den i verste fall kan gå på helsen løs. (NTB)

Bærum kommune ønsker å delta i en prøveordning der de overtar ansvaret for den offentlige tannhelsetjenesten.
Kommunen vil lettere kunne se utviklingstrekk i befolkningens tannhelse i sammenheng med andre helse- og sykdomsforhold og bruke det i forebyggende arbeid, heter de i vedtaket fra hovedutvalg bistand og omsorg.
Kilde: Budstikka
Odontologisk psykologi er en lærebok som omhandler de psykologiske sidene ved tannhelse og tannbehandling. Tannhelsen påvirker den mentale helsen vår, og psykiske vansker kan påvirke tannhelsen. I omtalen skriver forlaget at:
mange isolerer seg fordi de skammer seg over dårlige tenner
mange er redde for tannbehandling og unngår det i årevis
flere har vonde erfaringer som gjør at tannbehandling oppleves umulig
For å kunne forstå og hjelpe alle pasienter må tannhelsepersonell ha kunnskap og ferdigheter i kommunikasjon, angstproblematikk og traumebevisst tannbehandling. Forlaget mener boken «Odontologisk psykologi» bidrar med å plassere munnhelsen som en integrert del av generell helse og velvære.
Kilde: Gyldendal Akademisk

Nylig annonserte ingeniører fra Tufts University i Boston at de har laget små biosensorer som festes på tennene. De små sensorene overvåker helse og spisevaner, basert på inntak av salt, sukker og alkohol. Informasjonen sendes direkte til brukerens mobil.
Ved å lage en biosensor som sitter på tennene, mener Tufts-ingeniørene at de kan ta målinger fra spytt, og på den måten samle data over hva som har blitt spist og hvordan kroppen har reagert. – Sensorene består av følsomme elementer som responderer på pH og glukose. Målingene overføres enten trådløst eller fysisk ved å skifte farge

og form. Ved å kalibrere alle disse svarene kan vi finne ut av hva som skjer i munnhulen eller på overflaten av tennene, sier Fiorenzo Omenetto, en av ingeniørene bak prosjektet.
Omenetto mener sensorene ikke bare kan overvåke spisevaner, men også tannhelse og fysiologiske tilstander som utmattelse gjennom prøver av spyttet. Han presiserer imidlertid at dette krever at sensoren få bedre sensitivitet.
Kilde: Dagbladet
Statistisk sentralbyrå (SSB) har publisert artikkelen «Dyrere tannlegepasienter» med de siste dataene om behandlingsutgifter.
Artikkelen påpeker at tannhelsetjenesten har fått flere årsverk, men behandler i gjennomsnitt færre pasienter. SSB viser samtidig til flere gode grunner til denne utviklingen.
I 2017 ble det behandlet 0,5 pasienter per 1000 kroner i reallønnsutgifter. Det er en reduksjon på 27 prosent i 2008. I 2017 kostet det 2215 kroner å undersøke og behandle en pasient, mot 1613 kroner i 2008.

Hull i tennene og betennelser i tannkjøttet er en folkesykdom, og flere av dem som er rammet, er ikke klar over det selv. Det er blant funnene avdekket i tannhelseundersøkelsen Tromstannen. I alt ble 3000 innbyggere fra hele fylket innkalt til sjekk, og undersøkelsen hadde et oppmøte på over 68 prosent.
Halvparten av de under søkte hadde periodontitt, kronisk betennelse i tannkjøttet.
Kilde: Harstad Tidende


Seks av ti offentlige ansatte tannleger har sendt bekymringsmelding til barnevernet. Ingen i helsevesenet ser barna like mye som tannhelsetjenesten. De innkaller alle barn mellom 3 og 18 år til jevnlig kontroll, og tannleger har derfor en unik mulighet til å avdekke omsorgssvikt og overgrep. I 2017 meldte tannhelsepersonell over 850 bekymringer til barnevernet.
En landsomfattende undersøkelse blant over 1500 tannleger og tannpleiere i Norge (Brattabø 2016) viser at 60 prosent av dem som er ansatt i den offentlige tannhelsetjenesten, har sendt bekymringsmelding én eller flere ganger i løpet av karrieren.
Kilde: KK
Både leverandøren av det mest utbredte journalsystemet for tannklinikker og representanter for tannhelsesekretærene hevder at det pågår deling av passord ved norske tannklinikker.
Av Tellef Øgrim
Lasse Moe er daglig leder og grunnlegger av Opus Dental, som har 25 000 brukere fordelt på over 3500 klinikker i Skandinavia. Moe advarer mot slurv i omgang med passord og pålogging. – Jeg har hørt at flere tannklinikker bruker veldig svake passord, og at de noen ganger har samme passord for alle ansatte, sier Moe.
Nestleder i Tannhelsesekretærenes
Forbund (ThsF), Anne Gro Årmo, advarer ansatte ved tannklinikker sterkt mot å gå med på å dele passord med andre. – Du har ikke anledning til å låne bort passord. Det kan jo føre til at det ser ut som om det er du som har skrevet noe i systemet, mens det i realiteten er noen andre som har vært inne. Arbeidsgiver kan ikke pålegge ansatte å låne bort passord, sier Årmo.
Klare signaler
Årmo er både opptatt av at tannlegene er
seg bevisst sitt ansvar, og at den enkelte ansatte vet når han eller hun skal si nei.
– Vi vet at det foregår uregelmessig praksis. Vi har fått spørsmål om dette fra våre tillitsvalgte, sier hun.
Det er to forskjellige måter å bytte passord på som blir beskrevet overfor Paratmagasinet.
En går ut på at en tannlege logger seg inn på systemet, men lar en ansatt skrive inn i systemet på vegne av tannlegen, mens tannlegen er innlogget.
Det andre eksempelet er at en ansatt, for eksempel en tannhelsesekretær som skal ut i permisjon, blir bedt om å overlate sitt passord til en vikar.
Disse og andre varianter av det Lasse Moe i Opus kaller tendenser til slurv i informasjonssikkerheten ved private klinikker, strider mot gjeldende regelverk, ifølge Datatilsynet.

– En slik praksis er brudd på kravet til tilstrekkelig informasjonssikkerhet i personopplysningsforskriften kapittel 2, brudd på pasientjournalloven paragraf 22 og strider også mot helsepersonells taushetsplikt, opplyser Trude TalbergFurulund, senior kommunikasjonsrådgiver i Datatilsynet.
Hensikten med regelverket er ikke minst å hindre snoking i pasienters personopplysninger. Derfor skal det være mulig å se hvem som har vært inne i systemet. TalbergFurulund viser også til normen for informasjonssikkerhet i helsesektoren, som er tilgjengelig på nettstedet normen.no.
Hvem har ansvaret?
Ledelsen ved en bedrift, for eksempel tannlegen på en tannklinikk, vil alltid være ansvarlig for å følge regelverket gjennom å sørge for gode rutiner i en klinikk. Men ansvaret ligger også hos hver enkelt. – Helsepersonell har jo en yrkespålagt
Det er ifølge Lasse Moe i Opus tendenser til slurv i informasjonssikkerheten ved private klinikker, noe som også ifølge Datatilsynet strider mot gjeldende regelverk.

taushetsplikt. Derfor bør de melde fra om systemet er for dårlig. Her vil dette også kunne bli en sak for Helsetilsynet, sier TalbergFurulund i Datatilsynet.
Uaktsomhet kan straffes
Paratadvokat Anders Lindstrøm forteller at han fikk problemstillingen med bytte av passord på sitt bord for noen måneder siden, etter en henvendelse fra en tannhelsesekretær.
– Dersom personlige passord deles, vil det kunne medføre at uvedkommende går i pasientjournaler og leser sensitive helseopplysninger. Dette er selvfølgelig i strid med personopplysningsloven, sier Lindstrøm.
Han peker på at reglene først og fremst skal sikre at ingen uvedkommende leser pasientjournaler, men at dette også kan gi alvorlige problemer for eieren av passordet.
– I og med at sporingen i systemet vil bli knyttet til den som er eier av passordet, vil det kunne medføre at eieren av passordet feilaktig blir anklaget for å ha gått inn på et område som han eller hun ikke skulle ha vært inne på, sier han.
Personopplysningsloven paragraf 13 slår klart fast det ansvaret som ligger hos «den behandlingsansvarlige» når det gjelder informasjonssikkerhet.
– Dersom passord ikke har vært sikret, mener jeg man raskt er over i brudd på ansvaret etter personopplysningsloven, noe som i ytterste konsekvens vil kunne medføre straffeansvar etter lovens paragraf 48, sier Lindstrøm
Ifølge paragraf 48 kan grov uaktsomt eller forsettlig brudd på personopplysningsloven straffes med «bøter eller fengsel inntil ett år eller begge deler».
Kan få sparken
Geir Fjerdingen, som er rådgiver innen den offentlige tannhelsetjenesten i både Buskerud, Telemark og Vestfold, advarer den enkelte mot å gi seg inn på, eller la seg overtale til, en praksis som strider mot regelverket.
– Det som blir beskrevet her, er ikke akseptabelt. Passord skal være hemmelig. Dersom noen går inn i journaler man ikke har noe å gjøre med, kan det få direkte konsekvenser for ansettelsesforholdet, sier Fjerdingen.
Han sier at det innen offentlig tannhelse er god forståelse av hva som er god og dårlig praksis på dette feltet, og av hva regelverket slår fast.
Piratkopierer
I tillegg til ulovlig deling av passord sier Opussjef Lasse Moe at han gjennom de 25 årene systemet har
vært på markedet har oppdaget flere tilfeller av ulovlig kopiering av systemet fra en klinikk til en annen.
Kopieringen er ifølge Moe i Opus drevet av et ønske om å spare penger. En tannlege kan spare omlag 15 000 kroner på å slippe å kjøpe en ny kopi av programmet, avhengig av antall brukere. Moe advarer mot at ulovlig kopiering kan bryte mot EUs nye personverndirektiv og kan utløse bøter som svir.
– Vi greier ikke å hindre at noen kopierer databasen, men jeg forstår ikke at de gjør det, sier Moe.
Han viser til at hver enkelt installasjon av programmet er knyttet til en unik klinikk, med sine brukere og sin unike adresse. – I avtalen står det klart at installasjonen kun skal brukes der den er installert, sier han.
Kopierer til bi-klinikk
Moe kjenner til at noen tannleger som eier klinikker på flere steder, har kopiert databasen til bruk på flere steder. Men innbygget sikkerhet sørger for at dokumenter som skrives ut for pasienter da blir påført feil

adresse.
– Databasen er utstyrt med en «lickfil» med en signatur som inneholder tannlegens navn og adresse. Når et dokument blir skrevet ut, vet jeg at det har skjedd at man manuelt har rettet adressen for hånd dersom databasen opprinnelig hører hjemme i en klinikk på en annen adresse.
Programmet kan også kopieres til en annen tannlege, som ethvert annet program, ifølge Opussjefen.
Kan utløse bot?
Men han understreker at selv om dette er fysisk mulig, så er det et klart brudd på avtalen mellom Opus og kunden. Moe hevder dessuten at en slik kopiering bryter med GDPR, EUs personvernreglement, som denne sommeren etter planen blir innført i norsk rett.
– Det kan ifølge de nye reglene gi en bot på fire prosent av omsetningen. De som gjør dette, tar en høy risiko, sier han.
Moe sier at Opus oppdager ca. ett–to tilfeller av duplisering av programmet hvert år, men legger til at det først oppdages når noe går galt i systemet som må justeres eller repareres.
Ikke nytt
Generalsekretær Morten H. Rolstad i Den norske tannlegeforening sier at det selvsagt ikke er akseptabelt om det foregår bruk av journalsystemet som bryter med avtaler eller kontrakter.
– Dette er i så fall noe Opus Dental og Moe må ta opp direkte med dem det gjelder. Enhver ikkeautorisert eller uberettiget bruk av ITsystemer eller programmer bør påtales.
Til gjengjeld mener han at Moe sprer forvirring når han blander EUs nye personvernregler inn i denne saken.
– Det er ikke noe nytt at all behandling av person og helseopplysninger skal skje i tråd med norske lover og forskrifter. Norge har alt et godt utbygget regelverk på området, og NTF har gjort et betydelig arbeid for å bidra til at norske tannleger skal kunne følge dette, sier han.
Det er selvsagt ikke akseptabelt om det foregår bruk av journalsystemer som bryter med avtaler eller kontrakter.
Generalsekretær Morten H. Rolstad

Revisjon på gang
Rolstad peker på at reglene for person og helseopplysninger, herunder i tannlegevirksomheter, er spredt utover flere lover og forskrifter, og at den nevnte Normen for informasjonssikkerhet i helsesektoren for tiden er under revisjon slik at den skal stemme med GDPR (EUs General Data Protection Regulation).
– NTF har ingen oversikt over hva som er situasjonen hos hver enkelt tannlege, men vårt mål er selvsagt at slike rutiner skal være på plass og bli overholdt. Vi kan ikke gå god for at det skal være noen forskjell mellom yngre og eldre tannleger her, sier generalsekretæren.
I likhet med Datatilsynet understreker Rolstad klinikkenes ansvar for «å etablere og gjennomføre gode og trygge rutiner for å sikre alle pasienters person og helseopplysninger».
– Dette er en selvsagt del av vår informasjon og veiledning til våre medlemmer. Det har gjennom årene vært avholdt en rekke møter og kurs i NTFs regi med dette som tema – og det fortsetter vi med der behovet er til stede, sier Rolstad.
Tannleger og tannlegesekretærer er daglig i kontakt med kjemiske stoffer som kan føre til skader, som oftest i form av allergiske reaksjoner. Heldigvis er det flere måter å unngå å få stoffene på seg eller i seg.
Av: Claude R. Olsen
De kjemiske stoffene som skaper problemer for tannhelsepersonalet, kommer fra tannfyllingsmaterialer, desinfeksjonsmidler og engangshansker. For å unngå å utvikle allergier eller andre skadelige bivirkninger på arbeidsplassen er det viktig å kjenne til hvor disse stoffene opptrer, og hvordan personalet kan forebygge skader.
Ifølge den danske undersøkelsen «Helbred 2014» havnet tannleger og klinikkassistenter på topp tilisten over yrkesgrupper som hadde fått arbeidsbetinget eksem. 25,7 prosent av klinikkassistentene oppga å ha hatt eksem det siste året. Andelen blant tannleger, farmasøyter og dyrleger var 16,7 prosent.
Gir oversikt om hvor og hvordan
Tove Larsen fra København universitet, Jan Tore Samuelsen fra Nordisk Institutt for Odontologiske Materialer (NIOM) og Jeanne Duus Johansen ved Herlev
geforenings tidende, gjennom de viktigste skadevirkningene av tannfyllingsmaterialer og av biocider som brukes til å desinfisere.
De konkluderer med at skadene forebygges best med tiltak som «no touch»teknikk, gode luftavsug og bruk av personlige vernemidler som beskyttelseshansker, briller og munnbind eller maske.
Utfordrende tannfyllingsmaterialer Kvikksølv i amalgam er stort sett erstattet av resinbaserte kompositter som herder i munnen på pasienten. Men så lenge amalgam fortsatt befinner seg i pasientenes tenner, vil kvikksølv fortsatt være en risiko. Forskernes råd er å bruke vannkjøling og kraftig avsug når tannlegen pusser og borer i amalgam. Tannlegen bør også bruke nye, skarpe hardmetallbor så fyllingene ikke blir pulverisert under boringen.
Komposittene er ikke uten problemer
og materialene som brukes for å lage dem, har i uherdet form reaktive metylakrylmonomerer, som kan gi allergier. Tannhelsepersonalet unngår kontakt med huden med «no touch»teknikk, så de blir mest utsatt for metylakrylat i lufta. Den virvles opp i små konsentrasjoner når materialet lages, når tannlegen pusser og tilpasser fyllingen, og når gamle fyllinger fjernes.
Farlige biocider
Høy temperatur er den beste måten å desinfisere og sterilisere utstyr, for eksempel i en dentaloppvaskmaskin eller en autoklav, men i mange tilfeller er slik fysisk desinfeksjon ikke mulig. Da brukes kjemikalier, såkalte biocider. De er også potensielt skadelige for tannhelsepersonalet. Skadevirkningene kan være etsing og irritasjon av hud og slimhinner.


For å forebygge skade har både EU og de enkelte land laget forskrifter og lovpåbud om hvordan arbeidet ved tannhelseklinikken skal planlegges og tilrettelegges. EU har vedtatt en egen biocidforordning.
Den enkelte tannhelseklinikk skal ha utarbeidet bruksanvisninger for personalet som bruker de kjemiske stoffene.
I det daglig arbeidet handler det om å unngå søl, sprut og dannelse av aerosoler.
Forskernes råd er å unngå biocider i sprayform og å utføre desinfeksjon i lukket rom med avtrekk der det er mulig. Skyll alltid hendene med rennende vann etter at desinfeksjonen er avsluttet, og husk å bruke personlig verneutstyr som engangshansker, beskyttelsesbriller, munnbind og plastforkle.
De desinfiserende midlene som er mest velegnet på tannhelseklinikker, er klorforbindelser og alkoholer.
Skadelige hansker
For å gjøre bildet mer komplisert kan også hanskene som skal beskytte tannhelsepersonalet, gi allergier. Hansker av naturgummi (lateks) er tilsatt gummikjemikalier som skal øke slitestyrken og elastisiteten. Det gjøres også i en del syntetiske gummihansker.
Gummikjemikaliene er den hyppigste årsaken til arbeidsbetinget allergi. Den danske Sundhedstyrelsen anbefaler at latekshansker skal være pudderfrie og ha lavt innhold av allergifremkallende lateks. For å unngå allergi bør tannhelsepersonalet bruke nitrilhansker uten gummikjemikalier.
Teksten er basert på artikkelen «Kemiske stoffers skadevirkninger på tandklinikker» i Den norske tannlegeforenings tidende 2018; 128 nr. 2 skrevet av Tove Larsen, Jan Tore Samuelsen og Jeanne Duus Johansen.

• Bruk beskyttelseshansker ved vått arbeid, men bruk dem så kort tid som mulig.
• Sjekk at beskyttelseshanskene er hele, rene og tørre innvendig.
• Bruk bomullshansker inni beskyttelseshanskene for å beskytte og unngå fukt.
• Vask hendene i kaldt vann, skyll og tørk godt.
• Bruk alkoholbaserte desinfeksjonsmidler i stedet for håndvask med såpe når hendene ikke er synlig skitne.
• Ringer skal ikke brukes.
• Bruk en fuktighetskrem med høyt fettinnhold og uten parfyme.
• Fuktighetskremen skal fordeles over hele hånden, inklusive mellom fingrene og på oversiden av hånden.
• Pass godt på hendene i fritiden.
• Bruk varme hansker utendørs om vinteren.
Tannhelse-feltarbeidere i Verdal. Fra venstre: Tannlege Anders Sørhuus, tannhelsesekretær Elin
Walskra, tannhelsesekretær Anne Grete Ivarrud, tannhelsesekretær Hege Johannessen og tannpleier
Astrid Bøland Landre. Foto: Hedda Høvik.




Omfattende helseundersøkelser i befolkningen er kommet for å bli. Også for tannhelseteam er helseundersøkelser blitt en viktig aktivitet, som vi har sett under den store Helseundersøkelsen i Nord-Trøndelag. Snart er en egen forskrift om helseundersøkelser i befolkningen på plass.
Av: Magne Otterdal
Tannhelse kom med først i tredje runde av Helseundersøkelsen i NordTrøndelag (HUNT). Nå er forsker Hedda Høvik i full gang med å organisere flere tannhelseteam som skal foreta nye undersøkelser på befolkningen rundt om nord i Trøndelag fylke. Det er fjerde runde for HUNT, og andre runde for tannhelsesjekk som tilleggsprosjekt for HUNT.
Høvik er ph.d. og forsker ved Tannhelsetjenestens kompetansesenter i MidtNorge (TkMN). Hun opplyser at munn og tannhelseundersøkelsen i den pågående HUNTrunden, i tillegg til kartlegging av munn og tannhelse hos den
voksne befolkningen, vil konsentrere seg om mulige sammenhenger mellom oral helse og øvrige helse og sykdomsforhold. – Vi har tannhelsestasjoner på feltstasjonene i Stjørdal, Levanger, Steinkjer, Værdal, Namsos og Nærøy, sier Høvik til Tannhelsesekretæren.
På alle feltstasjonene er det satt opp fullt tannhelseteam med tannlegesekretær, tannpleier eller tannlege. – Jeg tror teamene synes dette er litt gøy, at en er med på noe som har større betydning for samfunnet, sier Høvik. Hun er på vei til Nærøy for å sette opp en ny feltstasjon.
All mengdetrening gjør en bedre, som å lære mer om hvordan pasienten skal stå når en tar panoramarøntgen, og hvilke feilkilder en kan oppdage.
Elin Braa
Tannhelsesekretær Elin Braa hadde stor glede, ikke minst faglig, av å delta i den store helseundersøkelsen HUNT i seks måneder. Det var både kompetanseøkende og mengdetrening som kommer til god nytte i det daglige arbeidet på tannklinikken i Stjørdal. Foto: Privat.

Fikk mengdetrening
Tannhelsesekretær Elin Braa deltok i prosjektet på feltstasjonen i Stjørdal, seks måneder fra september 2017 til februar 2018. Hun har bare godt å si om prosjektet.
– Det gir god og viktig kompetanseheving, sier hun.
I forkant fikk hun grundig opplæring ved TkMN. Hun jobbet i team med en tannpleier, og oppgavene besto i å ta røntgen, OPG, kliniske foto, spyttprøve og undersøke deltagerne klinisk. Hun journalførte opplysningene som ble samlet inn.
Hun tok 15–20 panoramarøntgen per dag, og hun fikk mye mengdetrening på enkelte funksjoner som er sjeldnere i det daglige der Braa jobber ved Stjørdal tannklinikk.
– All mengdetrening gjør en bedre, som å lære mer om hvordan pasienten skal stå når en tar panoramarøntgen, og hvilke feilkilder en kan oppdage, sier hun.
Alt i alt har Braa med seg en god porsjon nye erfaringer til det daglige arbeidet ved tannklinikken i Stjørdal, hvor hun jobber sammen med syv andre tannhelsesekretærer, to tannpleiere og fem tannleger.
I tannhelseundersøkelsen var to team fra tannklinikken i sving, med to dager i
uken hver. Arbeidsdagene var fra 08.00 til 19.00, og deltagerne ble kompensert med overtid og avspasering hver fredag.
4000 til tannsjekk
Ifølge Hedda Høvik vil denne fjerde runden i HUNT gi tannhelsedata fra over 4000 trøndere som frivillig kommer til feltstasjonene. Ved å delta i den storstilte helseundersøkelsen får deltagerne i alderen 19 til 100 gratis helsesjekk, og altså for andre gang får kandidatene sjekket tilstanden i munnhulen i tillegg til hjerte, nyre, lunge og alt det andre.
– Oral helse kan si noe om tilstanden i resten av kroppen, sier Høvik.
Som ansvarlig for tannhelseundersøkelsen er hun svært begeistret for oppgavene i forskningsprosjektet.
– Dette er kjempespennende, og jeg synes jeg har verdens fineste jobb. Det er veldig variert, og jeg får reist ut til klinikkene nord i Trøndelag og bli kjent med tjenesten. Det er en stor innsamling av data, som gir et unikt forskningsmateriale, sier Hedda Høvik.
Ny forskrift
Norge har sterke tradisjoner for store helseundersøkelser i befolkningen. Og det vil bli flere. Snart kommer en forskrift om befolkningsbaserte helseundersøkelser på
plass. Dette for å sikre hjemmelsgrunnlag som dekker både de innsamlede helseopplysningene og det humane biologiske materialet.
– Opplysninger fra undersøkelsene benyttes i folkehelsearbeidet til å følge med på helseutviklingen lokalt, regionalt og nasjonalt slik at en kan redusere risikoen for sykdom i befolkningen eller ved at sykdom kan oppdages i et så tidlig stadium at følgene reduseres, heter det innledningen til forskriftsforslaget som Helse og omsorgsdepartementet sendt på høring før jul 2017.
Undersøkelsene inneholder helseopplysninger og eventuelt biologisk humant materiale. Bruk av deltagernes data og materiale er basert på samtykke.
Data fra undersøkelsen brukes i forskning og analyser om sykdommers årsaker, utbredelse og forløp, om helsetjenester, om behandlingseffekter og om diagnoser. Det oppdages endringer i befolkningens helse, forhold som påvirker helsetilstanden, sosiale og geografiske forskjeller.
Evaluerer helseeffekten av politikk
Det pekes også på at de store helseundersøkelsene kan brukes til å evaluere effekten av ulike politiske tiltak og reformer, ikke bare i helsesektoren,
men også i andre sektorer – samferdsel, regionalpolitikken, skattepolitikken eller utdanning. Undersøkelsene gir muligheter for å gjøre framskrivinger av befolkningens helsetilstand.
– Helseundersøkelsene inngår sammen med biobanker og helseregistre i en grunnleggende infrastruktur for forskning på årsaker til helse, sykdom og hvordan dette fordeler seg i befolkningen, heter det i forslaget til helseundersøkelsesforskrift.
Flere befolkningsbaserte helseundersøkelser pågår: I tillegg til helseundersøkelsen i NordTrøndelag (HUNT) har vi Tromsøundersøkelsen, Saminor og Den norske mor og barnundersøkelsen (MoBa). Undersøkelsene er langsiktige der deltagerne følges over flere år.
Hver enkelt befolkningsbasert helseundersøkelse etableres i dag etter konsesjon fra Datatilsynet og eventuelt godkjenning fra en av de regionale komiteene for medisinsk og helsefaglig forskningsetikk.
Folkehelseinstituttet vs. fylkeskommunene Den nye forskriften vil gjøre det en del enklere å sette i gang en storstilt befolkningsbasert helseundersøkelse, mest sannsynlig med Folkehelsen som ansvarlig organ for håndtering av dataene fra helseundersøkelser. I forskriftsforslaget står det at enten Folkehelseinstituttet eller fylkeskommunen er databehandlingsansvarlig. – Vi mener Folkehelseinstituttet bør få rollen som databehandlingsansavarlig, heter det i høringsuttalelsen fra Folkehelseinstituttet ført i pennen av direktør Camilla Stoltenberg og områdedirektør Gun Peggy.
Ønsket om å samle ansvaret hos én institusjon begrunnes med stordriftsfordeler, enhetlig metode og innhold og ikke minst at data behandles i én nasjonal institusjon og gjøres tilgjengelig for statistikk, helseanalyser og forskning fra ett sted. – Et desentralisert databehandlingsansvar vil med stor sannsynlighet føre til mindre sammenlignbarhet mellom undersøkelser fra ulike deler av landet, og større risiko med hensyn til personvern og informasjonssikkerhet, skriver Stoltenberg og Peggy.

Statens skjermbildefotografering (senere Statens helseundersøkelser, SHUS) ble etablert i 1943 og gjennomførte etter andre verdenskrig landsomfattende undersøkelser av store befolkningsgrupper for å oppdage tidlige tegn på tuberkulose.
Totalt sett finnes det data fra skjermbildeundersøkelser for ca. 3,8 millioner personer, og data om høyde og vekt fra de samme undersøkelsene for ca. 2 millioner personer. Undersøkelsene ble utført ved hjelp av åtte ambulerende arbeidslag med seks skjermbildebusser og to skjermbildebåter. Arbeidet var sluttsteinen i bekjempelsen av tuberkulose som folkesykdom i Norge, og har stått som et internasjonalt mønsterprosjekt.
I 1972 startet Oslo-undersøkelsen, der kjente risikofaktorer for hjerte- og karsykdom hos menn ble kartlagt. Denne undersøkelsen ble senere utvidet til alle fylkene, delvis som regionale fylkesvise helseundersøkelser.
Etter hvert ønsket forskere å studere årsaker til andre kroniske sykdommer, slik som astma, diabetes, osteoporose, psykiatriske sykdommer og muskel- og skjelettsykdommer.
Undersøkelsene ble utvidet med blodprøver og fysiske målinger i tillegg til spørreskjema.
Statens helseundersøkelser gikk inn i Folkehelseinstituttet da det ble etablert i 2002. De regionale fylkesvise helseundersøkelsene ble ikke videreført etter 2003. (Kilde: Helse- og omsorgsdepartementet.)
Allerede i 1973 ble tannhelsen undersøkt gjennom Trøndelagsundersøkelsen. Da ble tannhelsen til gitte fødselskohorter i Trøndelag kartlagt i 1973 som del av WHO International Collaborative Study (WHO ICS-I). Dette ble fulgt opp med nye kartlegginger i 1983, 1994 og 2006.
I 2006 ble Trøndelagsundersøkelsen tilleggsprosjekt i HUNT 3. Den gangen deltok omtrent 400 personer til sammen, fra fire kommuner i Nord-Trøndelag; Levanger, Stjørdal, Verdal og Steinkjer.
I HUNT 4 samles data om munn- og tannhelse i større skala enn tidligere, både gjennom spørreskjema, biologisk materiale, klinisk munn- og tannhelseundersøkelse og ved uttrekk fra tannhelse-pasientjournal i forbindelse med Ung-HUNT.
Et tilfeldig utvalg på om lag 4000 personer over 19 år blir invitert til munn- og tannhelseundersøkelse i HUNT 4, i tillegg til personer som deltok i tannhelsestudien i HUNT 3. Klinisk undersøkelse utføres ved de store feltstasjonene i kommunene Levanger, Stjørdal, Steinkjer, Verdal, Nærøy og Namsos. (Kilde: Hedda Høvik.)

Det er viktig at rutinene for sterilisering i autoklaven er på plass på et tannlegekontor. I tillegg er mikrobiologisk kontroll av unitvannet nødvendig: Unilabs har ved flere anledninger påvist legionellabakterier i unitvann.
Av: Amalie Solnørdal Nærø
Sporeprøver i autoklaven gjør at tannlegekontoret er sikker på at autoklaven fungerer riktig. Unilabs er en av Norges største leverandører innen røntgen og laboratoriemedisin, og hos dem kan tannlegekontorer bestille prøvetakingsutstyr for å utføre sporekontroll av sterilisatorer og mikrobiologisk testing av unitvann.
Sporeprøver i autoklaven
Unilabs Laboratoriemedisin AS er delt inn i fire avdelinger; medisinsk biokjemi, medisinsk mikrobiologi, patologi og miljømikrobiologi. Sistnevnte er Åse Nysæter avdelingsleder for, og det er denne avdelingen som tilbyr utstyr til å gjennomføre sporeprøver på tannlegekontorer.
– Vi tilbyr sporeprøver som tester at
autoklaven, eller sterilisatoren, fungerer som den skal, ved at vi sender ut levende sporer og tester at de faktisk blir drept i steriliseringsprosessen. Da hender det at noen må ha vedlikehold av sterilisatoren sin, og det hender også at noen rett og slett har glemt å slå den på, sier Nysæter.
Hver kontroll inneholder seks testsporeprøver som skal legges på ulike steder i


Ved legionellasykdom bør det være rutiner for å undersøke om pasienten har vært hos tannlegen, mener Åse Nysæter ved Unilabs. Foto: Unilabs.
autoklaven. Unilabs anbefaler at tannlegekontoret kjører sporeprøvene i en full autoklav og behandler sporeprøvene som vanlig utstyr.
– Legg dem gjerne på utsatte steder som ved dør, i nederste hylle og i kassetter. Er noen av instrumentene innpakket, er det også lurt å legge noen innpakkede testsporeprøver, sier Nysæter. Noen ganger er det vekst i alle prøvene,
Det er ved flere anledninger påvist legionellabakterier i unitvann ved tannpleieklinikker. Når pasienter er syke av legionellabakterier, bør det være rutiner for å undersøke om de har vært hos tannlegen. Illustrasjonsfoto: Gorm K. Gaare.
mens andre ganger er det enkelte steder i sterilisatoren der steriliseringsprosessen ikke har vært tilfredsstillende.
– Vi ser også at det av og til slurves med hvordan autoklaven kjøres, så menneskelig svikt kan være årsaken til at vi får funn i prøvene. Det er jo nettopp det vi også gjerne vil avdekke, at rutinene som brukes er gode. Når en kontroll er positiv, ringer vi alltid kundene for å varsle om funnet, sier Nysæter.
Abonnementsordning
Unilabs tilbyr en abonnementsordning på sporeprøver, slik at tannlegekontoret kan gjennomføre jevnlige kontroller av autoklaven. Et slikt abonnement innebærer at tannlegekontoret får utdelt en årsutsendelse for å gjennomføre sporeprøvene. De får siden påminnelser om når prøvetaking skal utføres.
– Utstyret holder til fire kontroller i året. Abonnementet kan bestilles via telefon eller på nett, sier Nysæter.
Mikrobiologisk kontroll av unitvann
Unilabs Miljømikrobiologi tilbyr også mikrobiologisk kontroll av unitvann. Da undersøkes vannet blant annet for kimtall (generelt bakterienivå) og for legionellabakterier.
– Dersom unitvannet inneholder bakterier, kan det utgjøre en smitterisiko, fordi pasienten får vannet i munnen via utstyret tannlegene bruker, sier Nysæter.
Nysæter sier at de konsentrerer seg i hovedsak om funn av legionellabakterier i unitvannet.
– Vårt største fagområde er Legionella. Unilabs utfører legionellaanalyser for blant annet sykehus, hoteller, industri og eiendomsforvaltere. Vi bruker mye tid på undervisning, kursing og veiledning når det gjelder legionellaforebyggende arbeid, sier hun.
Legionellasmitte fra unitvann er en aktuell problemstilling, og Unilabs har ved flere anledninger påvist legionellabakterier i unitvann. I forbindelse med smitteoppsporing når pasienter er syke av legionellabakterier, bør det være rutiner for å undersøke om de har vært hos tannlegen.
– For Unilabs er det viktig å kunne gi kundene våre gode råd og veiledning i forbindelse med funn. Vi følger derfor kundene våre tett opp.
Lever prøvene så fort som mulig Tiden fra prøven er tatt til den blir analysert bør være kortest mulig. Nysæter sier at de har gjort en del tester på hvor lenge prøvene tåler å ligge før de blir for gamle til å analyseres. – Det er ikke veldig kritisk for sporeprøvene om det går noen dager, men det beste er å få sendt dem fortest mulig. Hvis vi ser at prøvene er gamle når vi mottar dem, ringer vi til avsenderen, sier hun.
Når det gjelder prøver av unitvann, er det knappere med tid, og de bør sendes så fort som mulig, fordi analysen bør utføres dagen etter.
Nysæter understreker hvor viktig det er å ha gode rutiner når det gjelder slike tester. Hun er spesielt opptatt av å teste unitvannet. Det er nemlig ikke like vanlig hos alle tannlegekontorer. Det er derimot ikke påbudt å gjøre det:
– Det er påbudt å gjøre en risikovurdering når det gjelder legionellasmitte, men ikke påbudt å teste unitvannet. Erfaringsmessig har vi påvist legionellabakterier i flere unitvann. Vi mener det er veldig viktig å være oppmerksom på dette, sier Åse Nysæter.
Tannhelsesekretærers pensjonsforhold er svært forskjellige, og er avhengig av hvor den enkelte jobber. I mange private tannlegevirksomheter velges minimumsløsningen på to prosent i den lovpålagte obligatoriske tjenestepensjonen (OTP).
Av: Sverre Bjørnholt
I det offentlige er det ryddig og med AFPordning. Innen privat sektor er det veldig mange steder mangel på AFP, tariffavtale og informasjon om rettigheter.
To AFP-ordninger
Pensjon fra folketrygden er vår viktigste pensjonsordning. I tillegg kommer tjenestepensjonsordningen som betales av arbeidsgiver. Hvor god tjenestepensjonen kan være, avhenger av innskuddet fra arbeidsgiver. Alle arbeidsgivere er pålagt å ha en pensjonsordning med minimum to prosent av lønn som pensjonsinnskudd.
Avtalefestet pensjon (AFP) er egentlig to forskjellige typer ordninger, en i privat sektor og en i offentlig sektor. Ordningen i privat sektor er en livslang utbetaling fra 62 år, mens i offentlig sektor har det frem til nå vært en tidligpensjon. I privat sektor er det mange som ikke har noen AFPordning.
Bør få orientering
På toppen av de kollektive ordningene kan den enkelte arbeidstager spare til pensjon selv som en individuell løsning.
– Det påhviler arbeidsgiver et ansvar for at ansatte har gode pensjonsforhold,
tariffavtale og AFPordning, sier forbundsleder Gerd BangJohansen i Tannhelsesekretærenes Forbund.
Hun sier arbeidsgiver bør gi ansatte en veiledning om pensjonens oppbygging, og også understreke hvor viktig det er for den enkelte å spare for egen del på toppen av den pensjonen de er sikret gjennom jobben.
– Det vil sørge for et stabilt og godt arbeidsmiljø. Jeg støtter også forslag om å løfte OTP tilskuddet godt over minimumsløsningen, helst opp til seks prosent, sier BangJohansen.
Bare én av fem med AFP Spesialrådgiver Kjell Morten Aune i Parats forhandlingsavdeling sier at det er mellom 2000 og 3000 tannhelsesekretærer og assistenter i privat sektor. Bare ca. 10 prosent av disse har en tariffavtale og dermed en AFPordning.
Når det gjelder tjenestepensjonsordningen, tyder alt på at arbeidsgiverne holder seg til minimumssatsen på pensjonsinnskudd – to prosent.
– Vi har ingen indikasjon på at arbeidsgiverne strekker seg lenger enn det, sier
Aune som er opptatt av å øke andelen tariffavtaler for medlemmene innen privat sektor.
Han tror også at pensjonsspørsmålet over tid vil bli løftet fram, slik at tannhelsesekretærer og tannhelseassistenter vil få bedret pensjonsforhold.
Også arbeidstagernes ansvar Camilla Hansen Steinum, president i Den norske tannlegeforening, sier at arbeidsgiver må ha kunnskap om pensjon, kjenne til ordninger og muligheter. Men hun mener at det også ligger et ansvar på arbeidstagerne for å orientere seg rundt temaet.
– Dette er et viktig tema som arbeidsgiver og arbeidstager bør diskutere for å finne gode løsninger som er tilpasset den enkeltes situasjon, sier hun.
– Er medlemmene av Tannlegeforeningen tilstrekkelig innsatt i pensjonsordningen?
– Pensjon er et er komplisert tema – både for arbeidsgiver og arbeidstager. Det krever en del å sette seg inn i temaet, og antageligvis er det mange som har behov for mer og oppdatert kunnskap. Vi informerer medlemmene om pensjon generelt, men vi anbefaler også medlemmene å få en annen rådgivning på området der det er behov for det, sier Hansen Steinum.
– Vil en tariffavtale med AFPordning være aktuelt for arbeidsgiverne?
– AFP er kun aktuelt i bedrifter med tariffavtaler. Dette er vanligst i offentlig

Pensjon bidrar til et stabilt og godt arbeidsmiljø, og tannhelsesekretærene ønsker OTPtilskuddet godt over minimumsløsningen, helst opp til seks prosent. Foto: Gorm K. Gaare.
sektor og i større bedrifter i privat sektor. Veldig mange av dagens tannlegebedrifter er relativt små og mange av dem har ikke inngått tariffavtale, og kan derfor ikke tilby AFP. Vi opplever også at veldig mange av dem som er ansatt i små bedrifter, ikke er spesielt opptatt av dette fordi de har gode betingelser og ordninger allerede, sier Hansen Steinum.
Begge parters ansvar
Tannlegepresidenten sier at det er vanskelig å si noe generelt om flyten av informasjon mellom arbeidsgiver og ansatte når det gjelder dagens pensjonsordninger. – Pensjon er et tema arbeidsgiver og arbeidstager bør ha dialog om, på samme måte som man har dialog og forhandlinger om lønn og andre betingelser. Dette er noe begge parter har ansvar for, sier Hansen Steinum.
– Vil en tilfredsstillende pensjonsordning
påvirke arbeidsmiljø og stabilitet i arbeidsstokken?
– Det er grunn til å tro at god lønns og arbeidsvilkår er viktig for arbeidsmiljø og stabilitet. Pensjon er en viktig del av et helhetlig bilde, sier Hansen Steinum.
Hun sier at de ikke har noen informasjon om at det er forskjell i holdningene til pensjonsordning mellom tannhelsekjedene og enkeltstående praksiseiere. – Vi vet at noen av de store kjedene har tariffavtale, og også AFP, men det gjenspeiler ikke nødvendigvis andre holdninger, men andre måter å organisere bedriften på. I de små bedriftene er det mindre forhold, men det er ingenting som tyder på at de ansatte i små bedrifter har dårligere betingelser enn ansatte i store bedrifter, eller motsatt, sier NTFpresident Camilla Hansen Steinum.

Spesialrådgiver Kjell Morten Aune i Parats forhandlingsavdeling konstaterer at arbeidsgiverne holder seg til minimumssatsen på pensjonsinnskudd. Foto: Parat.

NTFs president Camilla Hansen Steinum mener pensjonsordningene er et komplisert tema både for arbeidstagere og arbeidsgiver. Foto: Trygve Bergsland.
Utfallet av saken vil få prinsipiell betydning for hele norsk arbeidsliv.
Unio
Parat er forberedt på kamp og samler hovedorganisasjonene når Høyesterett til høsten skal behandle Parat-anken i en sak om reell arbeidsgiver, en sak som prinsipielt berører alle bransjer og virksomheter i Norge.
Av: Tellef Øgrim
YS, LO og Unio trer inn som såkalte partshjelpere for Parat i Høyesterett saken. Grunnen er at fagbevegelsen oppfatter spørsmålene som skal avklares som avgjørende for framtidens stillingsvern.
Betydning for norsk arbeidsliv
Unio, hovedorganisasjonen for universitets og høyskoleutdannede, skriver i sitt innlegg til Høyesterett at det som skal avklares er helt sentralt for Unios viktigste oppgaver som fagorganisasjon. – Ankesaken gjelder spørsmål av generell art som ligger i kjernen av de interesser
Unio skal ivareta som fagforening for medlemmene. Utfallet av saken har betydning for hvor effektivt stillingsvernet i norsk rett vil være framover. Potensielt berører ankesaken derfor interessene til alle medlemmer av Unio.
Unio er Norges nest største hovedorganisasjon med 360 000 medlemmer.
Hovedorganisasjonen har 13 forbund, blant andre Utdanningsforbundet, Norsk
Sykepleierforbund, Forskerforbundet og Politiets Fellesforbund.
Unio mener at «det endelige utfallet av saken vil få prinsipiell betydning for hele norsk arbeidsliv».
Truet stillingsvern
I innlegget beskriver Unio utviklingen av stillingsvernet slik: «Stillingsvernet utfordres av nye og uoversiktlige organisasjonsformer, flytting av arbeidsgiveransvar internt i selskapsstrukturen, inngåelse av lange kontraktskjeder og etablering av bemanningsforetak som leier inn personell til mor- og datterselskap. Slike disposisjoner, kombinert med etablering av uoversiktlige, selskapsrettslige konstruksjoner, har skutt fart. Utviklingen truer et effektivt stillingsvern, blant annet fordi plasseringen av det formelle arbeidsgiveransvaret bevisst eller ubevisst ikke ses i sammenheng med hvem som reelt sett har innflytelse over arbeidsforholdene.»
To temaer av stor betydning
Det er de prinsipielle sidene ved saken
som har brakt resten av fagbevegelsen inn i saken. Edvard Bakke er LOs advokat på saken. Høyesteretts behandling av anken vil ifølge Bakke avklare rettstilstanden i «to temaer av stor betydning for arbeidstakeres ansettelsesforhold».
For det første vil det ifølge LO komme en avklaring av hva som kan begrunne at andre enn den formelle arbeidsgiveren skal regnes som reell arbeidsgiver.
– For det andre vil en behandling av anken bidra til en klargjøring av rettstilstanden med hensyn til grensedragningen mellom innleie og entreprise i konsernforhold, og innholdet av normen «åpenbart urimelig» i arbeidsmiljøloven paragraf 1414 første ledd, skriver Bakke til Paratbladet.
Disse rettslige problemstillingene har ifølge LO de senere år i økende grad blitt aktuelle i det norske arbeidslivet.
Viktig for fellesskapet
Problemstillingene har så vel individualrettslige som kollektivrettslige implikasjoner.
Advokat i Parat, Christen Horn Johannesen, beskriver hvordan arbeidsgiver organiserer seg bort fra arbeidsgiveransvaret ved å flytte ansatte fra driftsselskapet til ulike bemanningsselskaper. Foto: Trygve Bergsland.

For den enkelte ansatte handler saken, ifølge LO, om «den enkelte arbeidstakers rett til et trygt ansettelsesforhold».
De kollektive konsekvensene er blant annet beskrevet i LOs handlingsprogram som peker på at: «… utviklingen i arbeidslivet bidrar til at den norske arbeidslivsmodellen utfordres blant annet som følge av at konsekvensen er at organisasjonsgraden svekkes og derved tariffavtalenes betydning».
– At LO og Norsk Flygerforbund har erklært partshjelp, bidrar til å synliggjøre at saken har betydning utover den konkrete saken til dem som er omfattet av søksmålet. I saker av generell betydning forekommer det, som her, at man erklærer partshjelp til fordel for parter i andre organisasjoner, skriver Bakke.
Viktig bekreftelse
Pilot Trond Torgersen er en av de elleve som står bak anken etter nederlaget i lagmannsretten. Han har fløyet for Norwegian i 20 år og er glad for støtten
fra alle hovedorganisasjonene, og tar den som en bekreftelse på at kreftene han har brukt på denne saken de siste årene har vært brukt til en god sak.
– Jeg tar det som en bekreftelse på at vi kjempet en viktig sak, sier Torgersen.
Han tror at støtten fra en samlet fagbevegelse vil kunne øke den politiske og prinsipielle betydningen saken har.
– Jeg vil tro at politiske myndigheter ikke kan unngå å fatte interesse for saken nå. Riktignok har jeg inntrykk av at den sittende regjeringen i utgangspunktet ikke er så opptatt av å hjelpe oss, men det blir vanskeligere for dem å ignorere dette spørsmålet nå, sier Torgersen.
Avklart i løpet av desember Paratadvokat Christen Horn Johannessen sier at partshjelpen, eller støtten, fra YS, LO og Unio har bidratt til at saken blir avklart i vår øverste domstol.
– Det har klart styrket sakens mulighet til å slippe inn til full behandling i Høyesterett. Dessuten vil partshjelpen
styrke oss i forberedelsene og gjennomføringen. Partshjelpserklæringene og bredden i støtten underbygger vårt syn om at saken reiser problemstillinger med betydning for hele det norske arbeidslivet, sier Horn Johannessen.
– Er det en måte å legge et element av politisk press på retten?
– Nei, ikke et politisk press, men tydeliggjøring av at dette er en viktig sak for Høyesterett og det mandat de har som en maktfaktor i Norge, sier Paratadvokaten.
– Hvor lang tid må man regne at det går før Høyesterett fatter sin beslutning i saken?
– Saken kommer opp fra 23. oktober til 1. november, der hovedforhandlingene går over syv dager, som er relativt langt. Deretter ca. fire uker før dom foreligger, altså i løpet av desember 2018, sier Horn Johannessen.


Mens den opphetede debatten om EUs energibyrå ACER gikk med full styrke i Norge, la Europakommisjonen fram et forslag om å opprette et arbeidsmarkedsbyrå innenfor det europeiske fellesskapet.
Av: Sverre Bjørnholt
Det nye byrået vil, om det går gjennom beslutningsprosessene i EU, være etablert fra 2019 med 140 medarbeidere med et årlig budsjett på drøyt 50 millioner euro og være fullt ut operativt i 2023.
Kamp mot arbeidskrim
Det var under EUs sosiale toppmøte i Gøteborg i november i fjor at EUkommisjonens president JeanClaude Juncker og de europeiske lederne ble enige om at «den europeiske søylen for sosiale
rettigheter» skulle etableres. Og i mars i år ble det besluttet at nettopp et europeisk arbeidsmarkedsbyrå skal være en av grunnpilarene i dette prosjektet.
En av dem som skal ha innvirket sterkt på dette utspillet, er vår egen statsminister Erna Solberg. I forkant av toppmøtet i Gøteborg skrev hun på vegne av regjeringen et brev til EU, der hun tok til orde for en felles kamp mot den omfattende kriminaliteten i det europeiske arbeidslivet.
Statsminister Solberg hevder at erfaringene i Norge tyder på at arbeidslivskriminaliteten er blitt mer omfattende og sterkere organisert enn tidligere. Hun mener sakene ofte har internasjonale forgreininger, og i mange tilfeller er det rene kriminelle nettverk som stadig flytter seg hurtig fra land til land.
EUs arbeidskommissær Marianne Thyssen sier til NTB at byrået vil være avgjørende
for å sikre et velfungerende europeisk arbeidsmarked.
Dette vil hjelpe mennesker og bedrifter som flytter på seg, til å finne riktig informasjon, og det vil styrke samarbeidet mellom medlemslandene for å håndheve rettferdighet og effektive regler, sier hun.
Europeisk arbeidstilsyn
Men hva er nå ELA? Ifølge eksperter skal byrået bli et slags europeisk arbeidstilsyn for å bedre samarbeide om arbeidslivsspørsmål og utgjøre en del av EUs arbeid med å styrke arbeidernes sosiale rettigheter innenfor det europeiske fellesskapet.
Ifølge Europabevegelsen bor og arbeider i dag 17 millioner EUborgere i et annet EUland enn sitt eget. Det er dobbelt så mange som for ti år siden. I tillegg pendler daglig 1,7 millioner EUborgere til et annet land.

Stortingsrepresentant og leder av Europabevegelsen, Heidi Nordby Lunde (H), mener et europeisk arbeidsmarkedsbyrå er et skritt i riktig retning. Foto: Hans Kristian Thorbjørnsen.
Byråets arbeidsoppgaver blir å takle utfordringene i et voksende arbeidsmarked som krysser nasjonale landegrenser. Det betyr at byrået skal gi informasjon om de rettigheter arbeidstagere og selvstendig næringsdrivere har om de arbeider i et annet medlemsland.
En annen arbeidsoppgave er å støtte samarbeid mellom nasjonale myndigheter og sikre at EUs felles regler forstås og håndheves på en rettferdig og effektiv måte på tvers av bransjer.
Grenseoverskridende inspeksjoner
Det er også meningen at byrået skal gjennomføre felles grenseoverskridende inspeksjoner med nasjonale myndigheter for å forhindre svindel og misbruk. Dessuten skal byrået mekle og legge til rette for løsninger av grensekryssende tvister. Dette kan blant annet skje hvis et selskap setter i verk omstruktureringer eller masseoppsigelser som rammer ansatte i flere land i Europa.
Årsaken til EUframstøtet er en stadig stigende misnøye innen EUlandene om at unionen er tynget av stor arbeidsløshet,

sosial dumping, arbeidslivskriminalitet og tyngende fattigdom. Det er lenge krevd tiltak som kan få bukt med disse problemene. Ifølge EUlederne skal arbeidsmarkedsbyrået være et skritt på veien. Nå vil EUkommisjonen ifølge NTB følge opp med et formelt lovforslag.
Vedum krever veto
Det gikk ikke mange dager etter signalene kom fra Brussel før debatten tok seg opp i Norge. En av dem som varsler kamp mot det nye byrået, er senterpartileder Trygve Slagsvold Vedum. Han mener at regjeringen i dette tilfellet må bruke sin vetorett.
– Det norske arbeidsmarkedet fungerer i hovedsak meget bra, og det er ingen grunn til at vi skal gi fra oss kontrollen over det. Ingen aktører på det norske arbeidsmarkedet ønsker EU inn, sier Vedum til Klassekampen.
Heller ikke lederen i Nei til EU, Kathrine Kleveland, er begeistret for EUs nye framstøt på det europeiske arbeidsmarkedet. – Det er i beste fall naivt å tro at et eget EUbyrå, som ikke bryr seg om annet enn EUrettens minimumsbestemmelser, skal
bli et bolverk mot sosial dumping, hevder Kleveland overfor FriFagbevegelse.no.
Støttespillere
I et blogginnlegg skriver Robert R. Hansen, LOs seksjonsleder for Europa, at han ønsker forslaget om et arbeidsmarkedsbyrå innen EU velkommen.
Han mener det vil styrke trepartssamarbeidet, og at innføringen av et slikt byrå vil styrke arbeidslivspartenes innflytelse på det arbeidet som gjøres i arbeidet mot sosial dumping og arbeidslivskriminalitet.
Også lederen av Europabevegelsen, Heidi Nordby Lunde, er begeistret over at EU tar tak i problematikken innen arbeidslivsområdet i Europa. Hun mener forslaget om å opprette et arbeidsmarkedsbyrå innen Europa er et viktig skritt i retning av et mer sosialt Europa. – Fri flyt av varer, handel og tjenester har vært positivt, men vi må erkjenne at det ikke har vært godt nok regulert og har bidratt til utfordringer mellom land. Nå tar EU grep for å løse de problemene, sier Nordby Lunde.
Ferie er for de fleste sol, sommer og tid sammen med familie og venner. Valg av tid for avvikling av ferie kan av og til skape noen problemer på arbeidsplassen. Vet du hvilke regler som gjelder dersom du blir syk i ferien, eller hvor mange feriedager du har rett til?
Av: Lene Liknes Hansen og Eva Borhaug
I et harmonisk arbeidsforhold vil partene som regel bli enige om når ferien skal tas ut og hvor lang ferie man tar om gangen. Det vil også være naturlig for arbeidsgiver å forhøre seg med arbeidstaker når man ønsker å ta ut ferie.
Hvor mange feriedager har du krav på?
Ferieloven legger opp til at arbeidsgiver skal drøfte feriefastsettingen med den enkelte arbeidstaker eller med de tillitsvalgte. Arbeidstaker kan kreve å få underretning om feriefastsettingen tidligst mulig og senest to måneder før ferien starter, såfremt ikke særlige grunner er til hinder for dette. Både underretning senest to måneder før og drøftingsplikten er såkalte ordensregler, noe som betyr at det ikke får noen konsekvenser dersom arbeidsgiver unnlater å følge disse reglene.
Alle, uansett stillingsprosent, har rett på fire uker og én dag ferie (25 virkedager –ferieloven opererer med lørdag som virkedag). I tillegg har de fleste som er omfattet av en tariffavtale rett på fem ukers ferie (30 virkedager). Ved bytte av jobb eller tiltredelse i ny jobb, har man som hovedregel rett til full ferie dersom man starter å jobbe i den nye stillingen senest 30. september i ferieåret. Arbeidstakere som tiltrer etter denne datoen har kun rett på ferie i seks virkedager. Begge tilfeller forutsetter imidlertid at det kan godtgjøres at full ferie ikke allerede er avviklet hos annen arbeidsgiver tidligere samme år.

Fyller du 60 år i løpet av ferieåret, har du rett på seks virkedager ekstra ferie. Denne ekstraferien kan tas ut akkurat som det passer deg, enten samlet eller med en eller flere dager om gangen. Deles ekstraferien, kan du imidlertid bare kreve å få fri så mange arbeidsdager som du normalt har i løpet av en uke. Du skal gi arbeidsgiver minst to ukers varsel før avvikling av denne ekstraferien.
Vær oppmerksom på at fridager i turnusarbeid eller deltidsarbeid også regnes som feriedager i ferieperioden. Disse dagene går altså til fradrag i ferietiden.
Er du usikker på hvor lang ferie du har rett på, kan du sjekke med HRavdelingen eller personalansvarlig.
Når skal ferien tas ut?
Det er mest vanlig å ta ut størsteparten av ferien i skoleferien. Hovedferieperioden etter ferieloven regnes fra 1. juni til 30. september. I denne perioden har arbeidstaker rett på tre uker sammenhengende ferie. Det er likevel arbeidsgiver som til syvende og sist bestemmer når ferien skal tas ut dersom partene ikke blir enige. Restferien kan også kreves tatt i sammenhengende arbeidsdager. Arbeidsgiver kan altså få problemer med å dele opp denne ved for eksempel å si at arbeidstaker må ta ut tre feriedager i påskeuken og to dager i romjulen. Har man den femte ferieuken vil dette bli enklere for arbeidsgiver. Her kan arbeidsgiver kreve at arbeidstaker tar
ut restferien samlet i påskeuken og deretter den avtalefestede ferien samlet i for eksempel romjulen.
Dersom ferien er fastsatt og du som arbeidstaker har mottatt informasjon om dette, kan arbeidsgiver som hovedregel kun endre tiden for ferie dersom dette er nødvendig på grunn av uforutsette hendelser som vil skape vesentlige driftsproblemer og det ikke kan skaffes stedfortreder. Endringer skal drøftes, og arbeidstaker kan kreve erstatning for dokumenterte merutgifter dersom avtalt ferie endres. Arbeidstaker plikter i så tilfelle å gi opplysninger om merutgiftene i drøftingene. Dersom man ikke gjør det, får man kun dekket merutgifter i den utstrekning de fremstår som nærliggende følger av omleggingen.
Disse reglene om endring av ferie gjelder likevel ikke dersom ferien endres som følge av ferieavvikling i oppsigelsestid eller ferieavvikling ved sykdom, permisjon, arbeidskamp eller lignende.
Ferieavvikling i oppsigelsestid
Dersom du har sagt opp stillingen din, kan du be om uttak av ferie i oppsigelsestiden. Dette krever enighet fra arbeidsgiver. Arbeidstaker kan kreve tre uker i sammenheng dersom oppsigelsestiden er i hovedferieperioden. Tiden for fastsatt ferie kan ikke uten arbeidstakers samtykke endres på grunn av oppsigelse, med mindre det er nødvendig på grunn

av uforutsette hendelser og dette vil skape vesentlige driftsproblemer der det ikke kan skaffes stedfortreder.
I situasjoner hvor arbeidsgiver har gått til oppsigelse av arbeidstaker, kan arbeidsgiver kreve at arbeidstager tar ut ferie i oppsigelsestiden, men kun dersom oppsigelsesfristen er tre måneder eller lengre. Ved kortere oppsigelsesfrist må arbeidstaker samtykke i at ferien blir lagt i oppsigelsestiden. Dersom arbeidstaker og arbeidsgiver allerede før oppsigelsen har avtalt ferie som faller i oppsigelsestiden, kan arbeidstaker likevel motsette seg avvikling av ferie i denne perioden.
Arbeidstaker kan uansett kreve at ferie avvikles før oppsigelsesfristens utløp, hvis det etter dette tidspunktet ikke er tid til å avvikle ferie innenfor hovedferieperioden eller ferieåret. Arbeidstaker som selv sier opp sin stilling etter 15. august, kan likevel ikke kreve at ferie legges til tiden før 30. september.
Hva om du blir syk i ferien?
Det hender at man blir syk i ferien. Hvordan skal man da forholde seg? Man må her skille mellom sykdom som oppstår før avtalt ferie starter og sykdom som oppstår i selve ferien.
Dersom arbeidstaker blir syk før ferien starter, kan man kreve at ferien utsettes til senere i ferieåret. Kravet må dokumenteres med legeerklæring og fremsettes senest siste arbeidsdag før ferien starter.
Blir man syk mens man har ferie, kan man kreve at et tilsvarende antall virkedager ferie utsettes og gis som ny ferie senere i ferieåret. Igjen må kravet dokumenteres med legeerklæring og må fremsettes uten ugrunnet opphold etter at arbeidet er gjenopptatt. Er man fortsatt syk etter at ferien er avsluttet, bør man så snart som mulig melde fra til arbeidsgiver om at man krever ferien utsatt. Dette kan for eksempel gjøres samtidig som man sender inn

sykemelding. Går det for lang tid, risikerer du å tape kravet om utsatt ferie.
Ferieavvikling under foreldrepermisjon
Arbeidsgiver kan ikke, uten arbeidstakers samtykke, legge ferie til permisjonstid hvor det ytes foreldrepenger etter folketrygdloven. Dette gjelder imidlertid ikke hvis man kun har gradert permisjon. Tilsvarende krav til samtykke ved ferie i permisjonstiden gjelder for fedre og andre omsorgspersoner som har permisjon i tilknytning til fødsel etter arbeidsmiljølovens bestemmelser om omsorgspermisjon.
Arbeidstaker kan likevel kreve å avvikle lovbestemt ferie i løpet av permisjonstid hvor det ytes foreldrepenger, slik det er beskrevet i folketrygdloven paragraf 149 om full foreldrepermisjon og paragraf 1416 om gradert foreldrepermisjon.
Faller permisjonstid sammen med allerede fastsatt ferie, kan arbeidstaker kreve utsettelse av de feriedagene som omfattes av permisjonstiden.
Overføring av ferie
Ifølge ferieloven kan man avtale med arbeidsgiver å overføre inntil tolv
virkedager av den lovfestede ferien til neste ferieår. Det samme gjelder den avtalefestede ferien. Dette innebærer altså at man kan avtale å overføre inntil 17 virkedager (14 arbeidsdager) totalt til neste ferieår, noe som må avtales skriftlig med arbeidsgiver.
Ferie som i strid med lovens bestemmelser eller på grunn av sykdom eller foreldrepermisjon ikke er avviklet ved ferieårets utløp, skal overføres til neste ferieår. Hvis arbeidsgiver er skyld i manglende ferieavvikling, kan arbeidstaker kreve erstatning. Husk at arbeidsgiver plikter å sørge for at arbeidstaker tar ut minst 25 virkedager i ferie hvert år, og at arbeidstaker har tilsvarende plikt til å avvikle disse feriedagene.
Rett til forskuddsferie
Man har rett til skriftlig å avtale forskuddsvis avvikling av ferie i inntil tolv dager.
Feriepenger
Feriepenger fra arbeidsgiver beregnes på grunnlag av lønn som er utbetalt i opptjeningsåret. Ved vanlig ferieavvikling får man utbetalt feriepenger av lønn opptjent året før. Dersom arbeidsforholdet avslut
• Unngå å ta med mye kontanter og svært kostbare gjenstander. Benytt helst kredittkort.
• Kontroller utløpsdatoen på kortet.
• Fordel kontanter og kort på flere steder, ikke ha alt i samme lomme eller veske. Ha heller ikke med deg for mye av verdi på stranden og lignende.
• Ha aktuelle varslingsnummer lett tilgjengelig i tilfelle sykdom, ulykke eller tyveri.
• Kontakt politi hvis du blir utsatt for tyveri. Få alltid en kopi av anmeldelsen.
• Kontakt nærmeste konsulat og reiseleder dersom du blir ranet og ikke har penger.
• Legg ikke verdigjenstander synlig i bilens kupé på bilferie.
Kilde: Finans Norge
tes, vil man ha krav på å få feriepenger utbetalt også for året man blir oppsagt, uavhengig av om det er tatt ut ferie det året.
Den vanlige prosentsatsen er 10,2 prosent av feriepengegrunnlaget. Arbeidstakere som omfattes av en tariffavtalt femte ferieuke har en prosentsats på tolv prosent. For arbeidstakere over 60 år med rett til ekstraferie forhøyes prosentsatsen ytterligere med 2,3 prosent.
Forholdet mellom ferie og feriepenger
En vanlig ordning er at arbeidsgiver utbetaler feriepenger i juli i stedet for lønn. Det er da viktig å være klar over at det ikke er noen direkte sammenheng mellom ferie og feriepenger. Ferie er rett og slett krav på fri uten lønn for en nærmere bestemt periode. Feriepenger er derimot krav på en tilleggsutbetaling for opptjent lønn.
Arbeidstaker kan kreve å få feriefritid uavhengig av opptjeningen av feriepenger. Tilsvarende kan arbeidstaker motsette seg avvikling av ferie i den utstrekning feriepengene ikke dekker lønnsbortfallet under feriefraværet.
• Ved reiser til områder med dårlige hygieniske forhold er det økt risiko for infeksjoner som smitter gjennom mat og vann. Symptomer er vanligvis diaré og oppkast. Smittestoffene drepes ved koking og steking.
• Vær forsiktig med kalde sauser, upasteuriserte melkeprodukter, ikkemeieripakket iskrem, mat tilberedt av rå egg (majones, desserter), salat, rå skalldyr og halvstekt eller rått kjøtt.
• Du kan trygt spise nylaget kokt eller stekt mat som fortsatt er varm, likeså frukt og grønnsaker som du selv skreller. Vær nøye med å vaske hender etter toalettbesøk, etter kontakt med dyr og før matlaging og måltider.
• Du kan drikke nykokt, varm te og kaffe og (mineral)vann fra flasker du selv åpner. Det frarådes vanligvis å drikke vann fra springen. Isbiter av forurenset vann er en velkjent smittekilde. Kilde: Folkehelseinstituttet

• Barn
Små barns hud er spesielt sårbar for sterk sol. Spedbarn bør unngå soling. Småbarn bør ha klær som dekker større deler av kroppen, eller holdes i skyggen.
Barn er også spesielt sårbare for sykdommer, særlig diaré. Før turer til Sør og ØstEuropa og tropiske/subtropiske strøk bør barn være fullvaksinert for sin alder med de vaksinene som inngår i barnevaksinasjonsprogrammet. For spedbarn kan vaksinasjonsprogrammet eventuelt fremskyndes. Spør på helsestasjonen i god tid før avreise.
• Gravide
Gravide utsetter seg for en viss risiko ved å reise utenlands, særlig til tropiske strøk og ved reiser under primitive forhold. Spør på svangerskapskontrollen.
• Kronisk sykdom eller funksjonshemming
Personer med kronisk sykdom eller funksjonshemming bør rådføre seg med legen sin før reisen. Det samme gjelder hivpositive personer med nedsatt immunforsvar eller andre med svekket immunforsvar, som lettere kan utvikle sykdom under utenlandsreise.
• Innvandrere
Etter noen år i Norge har innvandrere vanligvis ingen beskyttelse mot de hyppigst forekommende, smittsomme sykdommene i sitt opprinnelige hjemland. Det er derfor viktig at også innvandrere blir beskyttet med vaksinasjon og bruker forebyggende tiltak mot malaria også før de besøker tidligere hjemland.
• Vaksiner/forebyggende legemidler Informasjon om forebyggende tiltak fås hos kommunehelsetjenesten/fastlegen. Det gjelder også for vaksiner og nødvendige resepter. Ta kontakt i god tid. I noen tilfeller må vaksinasjonen begynne flere uker før avreise.
Kilde: Folkehelseinstituttet

Mye prisjuks avsløres av et europeisk tilsyn med reiselivsformidlere. Forbrukerombud Elisabeth Lier Haugseth sier best pris ikke alltid er best.
Rapporten viser at i en tredel av tilfellene var prisen som kunden først fikk se, ikke den endelige prislappen, og ett av fem markedsførte tilbud var likevel ikke tilgjengelig. Kunder blir også lurt til å tro at det bare er få ledige rom igjen på overnattingsstedet, mens det i virkeligheten er flere – bare at disse er tilgjengelige på andre nettsider.
– Man kan ikke gi inntrykk av at hotellovernattingen koster mindre enn den faktisk gjør. Den markedsførte prisen skal være totalprisen. Den skal inkludere alle utgifter du må betale, sier Lier Haugseth.
Ikke superbillig
Når det gjelder fly, legges billetter ofte ut superbillig på nettet.
– Men så ser vi at det påløper nye kostnader, som seteavgift, bagasjeavgift etc. Når du har kommet deg gjennom bestillingen, så ser du at du har fått en helt annen pris, men så orker du ikke å begynne på nytt, sier Lier Haugseth.
Hun sier også at sammenligningssider kan være forvirrende, fordi de ikke gjenspeiler alle tilleggsutgifter som plutselig kan renne på. Hun er også opptatt av at folk kan bli lurt av brukeromtaler av hoteller.
– Man må være klar over at brukeromtaler ikke gir det fulle og hele bildet av et hotell eller en leverandør. Ikke alle negativer omtaler kommer fram, eller omtaler kan være redigert. Vi har gjennom tilsynet sett at brukeromtalene ofte fremstår bedre enn de egentlig er, sier hun.
Forbrukere må sjekke informasjonen bedre, er budskapet. @ NTB
Gutta sa hun var for liten, skolens rådgiver at det ville bli for vanskelig. Det ga
Parat-medlem Janne Handrum (20) blaffen i. Nå lærer hun å mekke F-16, men drømmer allerede om å stramme grepet om mutterne på F-35.
En ung mann passerer. Hilser kjekt med hånda til panna, på militært vis. Seks–syv demonterte jetmotorer står langs en vegg. Et langt, sort forheng skjuler noe som er hemmelig.
Lærling på F-16 og Sea King Janne går i læra som flysystemmekaniker hos AIM Norway på Kjeller. Nå viser hun
AIM Norge har elleve lærlinger. Fem av dem er jenter. Men noen kvotering vil avdelingssjef Søisdal ikke gå med på. – Hos oss har det ingenting å si om du er jente eller gutt. Det som er viktig, er hva du yter. Om du har interesse og vil, sier han.
Søisdal sier AIM plukker de beste når de skal ta inn lærlinger.

– De må både ha gode karakterer og egne seg. Vi ser etter den spesielle typen; ungdommen som har interesse for faget, som graver seg litt ned, er nøyaktig og kan forholde seg til regler og rammer, sier han.
Tiden hos AIM Norge gir Janne og de andre lærlingene et gullkantet utgangspunkt. De kommer til å kunne velge og vrake i jobber. For som ferdig utdannet flymekaniker fra hangaren her på Kjeller kan Janne mekke på hva hun vil: Fly eller helikopter. Militært eller sivilt. Tog eller
Drømmer om Amerika
– Hva jeg driver med nå? Jeg tar ut en vingebolt. Det skal være inspeksjon i spantet der bolten sitter, sier Janne.
Halvparten av lærlingene hans er jenter, men
Anders Søisdal, sjef for Flyavdelingen hos AIM Norway på Kjeller, avviser alle tanker om kjønnskvotering.
– Nei, det driver vi ikke med. Her er det kun egnethet som teller, sier han.
Janne Handrum går i læra som flysystemmekaniker hos
AIM Norway. Her lærer hun blant annet å reparere og vedlikeholde norske jagerfly.
Handrum går i lære som flysystemmekaniker hos
AIM Norway. Interesserer: bilsport, dans og reiser. Liker å skru på motorer. Fikk sin første motorsykkel som femåring. Følg
Janne på Snapchat (Janne98) eller Instagram (ambassadorhandrum).


Myndighetene ønsker å øke unges interesse for yrkesfaglige utdanningsvalg, antall lærebedrifter og læreplasser. Worldskills Norway (WSN) er ansvarlig for kampanjen. Få informasjon på yrkesfag.no, enten du er elev, lærer, forelder eller representerer en bedrift:
#yrkesfag, #yrkesfagenesår eller #mittyrkesfag.

Med fagbrev som flysystemmekaniker kan Janne Handrum velge og vrake i jobber. Hun vil være kvalifisert som mekaniker for fly, helikopter, tog eller båt.
Hva som er drømmen min? Målet akkurat nå er å ta fagbrevet, men jeg kunne godt tenke meg å sitte i USA og skru på F-35, sier Janne.
Bedriften reparerer og vedlikeholder fly og helikoptre og holder til ved Kjeller flystasjon utenfor Lillestrøm. Forsvaret er hovedkunde. De største oppdragene er vedlikehold og modifikasjoner av F-16 og Sea King. AIM Norway har ca. 470 ansatte.
Hun synes dette er artig. – Har vært i Bodø og demontert en del vinger. Det blir enda mer moro når du har gjort en jobb ofte. Da kan du være mer selvstendig, sier hun.
– «Janne!» hoier en kar i arbeid på en annen F 16maskin. – Får jeg låne den halttomovergangen av deg ganske kjapt?
– «Ja!» roper Janne tilbake.
Hun spretter lettbeint over skroget på kampflyet og ned på betongen.
– Vi driver med tungt vedlikehold på flyene, sier ungjenta, tilbake på stillaset som omslutter den smekre flykroppen.
Hun forklarer at de går inn i systemet, inspiserer og reparerer.
– Ellers er strukturen i skroget eget fagområde på F16, sier hun.
Uka etter ventes tre flunkende nye F35, rapporterer Forsvarsdepartementet. De flys over fra fabrikkanlegget i Texas og lander på Ørland flystasjon utenfor Trondheim. Da vil Forsvaret ha seks av de nye F35 stasjonert på norsk jord. I tillegg står syv slike kampfly på en amerikansk treningsbase.
I løpet av de to neste årene vil trening av piloter og vedlikeholdspersonell bli svært viktig. De nye flyene vil først være fullt ut operative i 2025.
– Hva som er drømmen min? Målet akkurat nå er å ta fagbrevet, men jeg kunne godt tenke meg å sitte i USA og skru på F35, sier Janne.
Framtida er åpen. – Jeg flytter dit det er nødvendig. Jeg blir neppe arbeidsledig, sier hun.
Ambassadør for #yrkesfag 2018 er blinket ut som «Yrkesfagenes år». Målet er å få flere ungdommer til å velge yrkesfag. Arbeidslivet trenger dem.
I likhet med de andre lærlingene hos AIM Norway er Janne medlem av Parat. Slik ble det til at hun sa ja til å stille opp som ambassadør for kampanjen. Gjennom året skal hun fortelle andre ungdommer hvordan det er å utdanne seg til et yrkesfag.
For Jannes egen del var det ikke opplagt at hun skulle til Kjeller og mekke jagerfly. Det var mange som «ikke hadde trua», som hun selv uttrykker det.
– Pappa, som er bilmekaniker, ble med meg på masse yrkesmesser. Sammen så vi på de forskjellige løpene du kunne gå. Pappa har vært positiv hele veien. Mamma, som er regnskapsfører, sa: «Gjør det du har lyst til å gjøre.»
Valget falt på elektro. – Da fikk jeg høre av gutta at det kunne jeg ikke, fordi jeg var jente. Og så var jeg jo så lita. Men jeg tenkte at jeg skal vise dem at det går an.
Elevene skulle velge retning videre, og flyfaget kom opp som en av flere muligheter. – Igjen fikk jeg høre at jeg ikke kunne. Rådgiveren mente det ville bli for vanskelig å komme inn. At det ikke var noen vits i å prøve. Igjen ble jeg irritert på at folk ikke hadde trua.

Handrum er YS-ambassadør under «Yrkesfagenes år 2018». Ved å fortelle om egen læretid skal hun motivere flere ungdommer til å velge yrkesfag. – Lytt til deg selv og dine egne ønsker. Ikke foreldre eller venner, er Jannes klare råd.
Janne søkte. Fikk plass og hadde det som plommen i egget.
– Jeg følte meg veldig velkommen på flyfaget og stortrivdes. Nå kan jo de som ikke hadde trua se at jeg har fått det til. Selv om jeg er jente og lita, sier Janne.
Berg-og-dal-bane-junkie
Norge har i alt 57 F16 per dags dato, men som skal erstattes av F35 etter hvert. Hva som da skjer med basen på Kjeller, er usikkert, for øvrig en av verdenes eldste baser i operasjon.
Ifølge Anders Søisdal er det mulig AIM Norway flytter basen til den militære flyplassen på Rygge i Østfold.
– Det er ikke avgjort, men det som er sikkert, er at vi kommer til å jobbe med fly i en eller annen form, sier Søisdal.
Dagen før Paratbladets besøk var forsvarsminister Frank BakkeJensen på AIM. – Når forsvarsministeren kommer på besøk, gjelder det å ha noe å gjøre, å se litt opptatt ut. For da slipper du å bli spurt om ting, smiler Janne lurt.
En prøvetur med ett av flyene hun jobber med synes hun derimot ikke virker det minste skummelt.
– Jo, jeg kunne godt tenke meg å få sitte på med et F16 en gang. Det hadde vært kjempegøy. Jeg har sittet på med helikop
ter. Jeg er en bergogdalbanejunkie, sier hun.
Søisdal sier han har jobbet her i snart 28 år, men ikke fått fly med et F16 ennå, antagelig for å skru ned eventuelle forhåpninger om det umulige.
Men det er ikke godt å vite hva det er mulig å få til når det gjelder Janne. Hun har nemlig trua.

Parat-leder Hans-Erik Skjæggerud er leder for YS-komiteen som deler ut likestillingsprisen 2018.
Likestillingsprisen blir delt ut på YSkonferansen 30. Oktober, og vi trenger din hjelp til å finne den beste kandidaten. Formålet med prisen er å stimulere til økt innsats i arbeidet for å fremme likestilling og like muligheter for alle. Med likestilling mener vi alle tiltak som virker til å rette opp skjevheter når det gjelder muligheter til samfunnsdeltakelse, utdanning, arbeid og faglig utvikling.
Prisen kan gis til enkeltpersoner, grupper, organisasjoner samt private eller offentlige virksomheter, og både innen og utenlands. Godt begrunnede forslag kan sendes inn på www.likestillingsprisen.no eller www.ys.no innen 15. august.
Parat har fått nye websider. Den nye siden skal gjøre det enklere å finne det du er på jakt etter. Det første som møter deg, er spørsmål om hva vi kan hjelpe deg med. Den nye siden bruker Google som søkemotor, men søket er avgrenset til innhold på Parats sider.
Den nye hjemmesiden skal være like bra på mobil og nettbrett som på PC og Mac.
Parat.com har ikke lenger nyheter. Nyhetene er samlet på parat24.com. Parat24 er underlagt Redaktørplakaten og Vær varsomplakaten. Har du tips til forbedringer, kan du sende dem til webmaster@parat.com

Nye nettsider for web og mobil på www.parat.com.

Parats leder HansErik Skjæggerud gir honnør til Equinor (tidligere Statoil) for innføringen av en global ordning med 16 ukers foreldrepermisjon. – Equinor har med dette iverksatt et bra tiltak for den enkelte ansatte rundt om i verden som ikke har slike rettigheter gjennom nasjonale velferdsordninger. Det er også et viktig signal til omverdenen om hva vi i Norge mener må til for å bedre likestilling mellom kjønnene, sier Skjæggerud.
Parats hovedstyre har oppnevnt Reidun Nordgulen fra region vest som ny representant i det sentrale pensjonistutvalget i Parat. Utvalget består nå av Tore Grini (leder), John Giæver og Reidun Nordgulen.
Parat Pensjonist skal gi tilbud om sosiale, kulturelle og faglige aktiviteter for pensjonistmedlemmer i Parat. Det er aktive pensjonistgrupper i Oslo/Akershus, Hordaland og i Trøndelag. I tillegg er det kontaktpersoner i Vestfold, Telemark og Nordland.
For å opprettholde medlemsfordelene i Parat etter yrkeslivet er det en fordel å være medlem for blant annet å beholde gode forsikringsordninger. Husk å melde fra til medlem@parat.com når du går av med pensjon.

Leder for Parat Pensjonist Tore Grini. Foto: Parat.
AnnBritt S. Gjølstad fra Finn.no ble årets tillitsvalgt i Parat Media. Hun er tillitsvalgt i Finn.no, og prisen ble delt ut av Parat Medias leder på årets representantskapsmøte som ble avholdt i Nice i Frankrike.

Leder i Parat Media Liz Ovesen beskriver årets tillitsvalgt som en dame som kjennetegnes ved sin standhaftighet og ved sin løsningsorienterte tilnærming til problemer som dukker opp.
RU region Nord (Finnmark, Troms, Nordland):
Leder: Lars Raymond Holm, Luftfartstilsynet
Epost: Lrh@caa.no
Johanne Hagerupsen, Høgskolen i Harstad
Epost: johanne.hagerupsen@hih.no
AnneKatrine Thomassen, Brønnøysundregisterne
Epost: akt@brreg.no
TorFredrik Olsen, Finnmark Fylkeskommune
Epost: tor.fredrik.olsen@ffk.no
Åse Helen Andersen, Apotek 1 Hammerfest
Epost: aasehelande@hotmail.com
Terje Grytdal Roland, NordTroms Tingrett, UNGrepresentant
Epost: terje.grytdal.roland@domstol.no
RU region Midt (Trøndelag, Møre og Romsdal):
Leder, Jannike Hanssen, Statens vegvesen
Epost: Jannike.hanssen@vegvesen.no
Morten Mørch, NTNU
Epost: Morten.morch@ntnu.no
Siri Finseth, Namsos kommune
Epost: SiriStinessen.Finseth@namsos.kommune.no
Grete Kambuås, Boots Apotek
Epost: gretkam@online.no
Marit Holstad Aarsæther, Høgskolen i Volda Epost: maritaa@hivolda.no
Mona Nerland, Politiet i Molde, UNGrepresentant
Epost: mona.nerland@politiet.no
RU region Øst (Østfold, Hedmark, Oppland, Oslo og Akershus):
Leder: Hilde Margrete Bjørklund Cappelen Damm AS Epost: hilde.bjorklund@cappelendamm.no
Bente Iren Tollefsen Moen Statens Pensjonskasse
Epost: bente.iren.moen@spk.no
Stein Grindheim SAS Ground Handling Epost: stein.grindheim@sas.no
Leder i Parat UNG, Idar Gundersen, er YS’ deltaker på Genèveskolen. Formålet med skolen er å øke felleskapets forståelse av det nordiske samarbeidet og øke bevisstheten om globalisering og internasjonalisering, i tillegg til økt kjennskap til ILO og andre internasjonale organisasjoner.

Genèveskolen foregår samtidig som ILOkonferansen (mai/juni), og deltakerne på skolen følger konferansen tett. I år jobber ILOkonferansen blant annet med å få på plass en konvensjon om vold og trakassering i arbeidslivet.
Ronny Kjønsø Asko Øst Epost: ronny.kjonso@asko.no
Anja P. Ahlstrøm – NIBIO Epost: Anja.Ahlstrom@nibio.no
Hans Andreas Bøhmer, Securitas i Oslo, UNGrepresentant
Epost: hanboh@gmail.com
RU region vest (Rogaland, Hordaland, Sogn og Fjordane):
Leder: Rune Skaar, Bergen kommune
Epost: rune.skaar@bergen.kommune.no
Vidar Alfei, NAV Økonomitjeneste Epost: vidar.alfei@nav.no
Hege Solbakken Sæbø, Stavanger Aftenblad AS Epost: hege.solbakken.saebo@aftenbladet.no
Wibecke Søraas Onarheim, Gulating lagmannsrett Epost: wibecke.soraas.onarheim@domstol.no
Gro Nondal Buvik, Sognekraft AS Epost: gro.nondal.buvik@sognekraft.no
Erik Andreassen, Gate gourmet i Bergen, UNGrepresentant
Epost: eandreassen@gategourmet.com
RU region Sør (Aust og Vest Agder, Telemark, Vestfold og Buskerud):
Leder: Ragnhild Negård – NAV
Epost: ragnhild.negard@nav.no
Nina Ødegård – Høyskolen i Buskerud og Vestfold
Epost: Nina.Odegard@hbv.no
Cecilie Holt, NAV
Epost: cecilie.holt@nav.no
JohnInge Nerland – Fylkesmannen i Buskerud
Epost: fmbujin@fylkesmannen.no
Anne Britt Skomedal, Vitusapotek Elefanten Kristiansand Epost: annebritt1962@hotmail.com
Lahvry Helene Fürst Bright, UNGrepresentant
Epost: lahvry@hotmail.com
Vi som gir svar i denne utgaven av Parat er:






Har du spørsmål til juristene eller til forhandlingsavdelingen, kan du sende spørsmålene til trygve.bergsland@parat.com. Vi hjelper deg som medlem med alle typer problemstillinger knyttet til arbeidsforhold og tolkning av avtaleverket. Du kan også ta kontakt med oss når det er behov for skriftlig og muntlig rådgivning i forbindelse med omorganisering, nedbemanningsprosesser, ferie, arbeidstidsordninger, trygdespørsmål og lignende.
Antall feriedager
Vi har rett til fem ukers ferie på jobben og har fått beskjed av arbeidsgiver at vi kan dele en ferieuke, og ta enkeltdager ferie. Jeg jobber 80 prosent stilling og har fri hver fredag. En vanlig arbeidsuke er jo fem dager, men arbeidsgiver sier jeg bare får fire enkeltdager ferie. Er dette riktig?
Amelia
Svar: Det er riktig at stillingsprosent og arbeidstidsordning har betydning for hvor mange feriedager du kan ta når ferien deles. Ferie etter ferieloven, som er fire uker og én dag, har ingen bestemmelse som gir klar rett til å dele ferien. Lovens system bygger på at ferie skal tas i hele uker. Men det er selvsagt mulig å avtale at også denne ferien deles. I tillegg har dere tariffavtale på arbeidsplassen, noe som gir rett til ytterligere fire
dager ferie (ved femdagers uke). Denne ferien har dere en avtalefestet rett til å dele. Bestemmelsen sier at «deles den avtalefestede ferien, kan arbeidstaker bare kreve å få fri så mange dager som vedkommende normalt skal arbeide i løpet av en uke». Så hvis du jobber 80 prosent, og har fire dagers uke, vil du ha rett til fire enkeltdager ferie.
Grete
Går arbeidsavtalen foran tariffavtalen?
I arbeidsavtalen min står det at jeg har rett på ekstra godtgjørelse for å komme på jobb fordi jeg har lang reisevei. Men nå har min fagforening gått med på et ønske fra arbeidsgiver om å spare penger, og ifølge tariffavtalen har ingen ansatte rett på godtgjørelse for oppmøte på jobb uansett reisetid og lengde. Arbeidsgiver mener det innebærer at jeg mister min individuelt avtalte rett på denne ekstra godtgjørelsen som årlig sikrer meg 10 000 kroner. Det kan da ikke være riktig?
William
Svar: Jo, det er slik at den kollektive avtalen din fagforening har inngått på vegne av fellesskapet, går foran den individuelle. Det følger direkte av arbeidstvistloven paragraf 6: Bestemmelse i arbeidsavtale som strider mot en tariffavtale som begge parter er bundet av, er ugyldig.
Denne bestemmelsen beskyttes tariffavtalens verdi som normgivende. Da kan den ikke uthules eller settes til side av arbeidsgiver ved å inngå individuelle avtaler som undergraver avtalen. Samtidig innebærer dette at de tillitsvalgte har mye makt og ansvar når de forhandler på medlemmenes vegne. Det er på den måten fagforeningenes mulighet til å påvirke lønns- og arbeidsvilkårene sikres for alle. Det er bare dersom det er direkte motstrid mellom din individuelle avtale og tariffavtalen, at den individuelle avtalen må vike. Som oftest vil det ikke være motstrid, og da utfyller de to avtalene hverandre.
Christen
Foreldrepermisjon
Jeg jobber på et sykehus i Oslo, og til sommeren venter jeg og min kone vårt første barn. I den forbindelse lurer jeg på om det stemmer at jeg i tillegg til avtalt foreldrepermisjon har rett til to uker permisjon med lønn i forbindelse med fødselen?
Martin
Svar: Ja, det stemmer. I henhold til gjeldende avtale skal arbeidstaker som tar omsorgspermisjon etter bestemmelsene i arbeidsmiljølovens være sikret fri med full lønn i to uker (ti dager). Permisjon etter denne bestemmelse skal normalt avvikles i løpet av de første to ukene etter hjemkomst.
Renate
AFP – tariffavtale og rettigheter for enkeltpersoner
Jeg har nylig meldt meg inn hos dere. Grunnen til innmeldingen er at jeg har lest om fordelene med avtalefestet pensjon (AFP). Vi er 200 ansatte, og det er ingen som har AFP i dag. Hva skal til for at jeg kan omfattes av en AFPordning, og trenger dere ytterligere informasjon fra meg for å få dette på plass?
Thea
Svar: For å kunne få opprettet en AFPordning i en bedrift i privat sektor, så må det først opprettes en tariffavtale i virksomheten. AFP er ingen individuell rettighet, det er en kollektiv rettighet – som gir enkeltpersoner rettigheter når tariffavtale er på plass og øvrige vilkår er til stede.
For at Parat skal kunne opprette en tariffavtale, må vi først ha et tilstrekkelig medlemsgrunnlag i bedriften for å få opprettet en tariffavtale. Er arbeidsgiver medlem av en arbeidsgiverforening, kreves det at ti prosent av de aktuelle er medlem av Parat. Dersom bedriften ikke er organisert, bør vi som hovedregel ha om lag 50 prosent av de ansatte som medlemmer i Parat. Når tariffavtale er opprettet, meldes virksomheten inn i AFP-ordningen. Bedriften må betale premie inn til ordningen, og alle ansatte i en virksomhet er dermed omfattet av ordningen. For at den enkelte skal kunne benytte seg av ordningen, så må de individuelle vilkårene være oppfylt, se eventuelt afp.no for mer informasjon.
Kjell Morten
Ferie og sykdom
Jeg tok ut en ferieuke tidligere i måneden. Dessverre ble datteren min syk samme uke, og jeg brukte to av dagene til å passe på henne. Kan jeg få disse fridagene tilbake, og kan jeg bruke dem senere? Hadde jeg ikke hatt ferie, ville jeg jo uansett måttet være borte fra jobb.
Yngvil
Svar: Ferieloven inneholder regler om at en arbeidstaker som har vært syk i ferien, kan kreve ferien utsatt, og at sykedagene gis som ny ferie senere. Rettighetene i ferieloven gjelder arbeidstakers egen sykdom. Det er dessverre slik at dersom det ikke er du selv som er syk, men bruker ferien til å pleie sykt barn, gir ikke dette rett til ny ferie.
Maren
Promilleregler i båt
Jeg liker å være på Oslofjorden med snekka mi, og jeg liker å ta noen pils. Jeg kan ikke kjøre bil etter en slik tur, men jeg er usikker på om jeg kan bli promilledømt på fjorden. Snekka går sakte, og jeg har god styring hele veien.
Johannes
Svar: På sjøen kan du ha maksimalt 0,8 promille for å føre en båt. Dette gjelder småbåter som har motor som framkomstmiddel. Du bør derfor ikke drikke alkohol når du er på tur med snekka. Blir du kontrollert av politiet, blir du straffedømt. Om du har årer i båten, kan du kanskje komme unna, men i småbåtloven er det et krav om at du må være skikket om du skal føre en båt, også en robåt. Det beste vil derfor være å unngå alkohol når du skal føre en båt.
Thore

Løsningen på kryssordet i medlemsbladet Parat nummer. 1 – 2018 er: «BLIKKSTILLE IDYLL»
Den heldige vinneren er: Hege Dahl Moen, fra Trondheim. Frist for å sende inn løsning på neste kryssord er: 3. september 2018.
Vi trekker én vinner hver gang. Send løsningen til redaksjonen, enten som e-post til trygve.bergsland@parat.com eller ordinær post til: Parat, Postboks 9029, Grønland, 0133 Oslo
Løsning:
Husk å merke e-posten/konvolutten «Kryssord 2/2018» Husk også å skrive på ditt eget navn og adresse.
Premie: Elvang Latitude alpakka-pledd av 50 prosent alpakkaull, 40 prosent fåreull og 10 prosent mikrofiber. Pleddet er Fair Trade-sertifisert. Målene er 130x200 centimeter (se foto).

Vannrett
1. Liggeunderlag
6. Urørlig
7. Fikk øye på
10. Søtsaker
11. Krydderblanding
12. Engelsk bestemt form 14. Ledd
16. Ledelse 17. Loslitt 19. Fangstredskap
1.
2.
3.
4. Kappe
5. Lealaus 8. På grunn av 9. Øst-Tyskland 11. Babbel
13. Glød 15. Kolle
18. Oss to
Alle feltene skal fylles med tall. Noen tall er fylt inn på forhånd, og dette utgjør summen av tallene i de to feltene under. Du må sette inn begge tallene i de to tilstøtende feltene for å finne tallet i feltet over, og motsatt, du finner tallet i et felt ved å trekke tallet i feltet ved siden av fra tallet i feltet over.
Lett
Bokstavene i ordet under har blandet seg litt. Kan du nne fram til riktig ord ved å plassere bokstavene i riktig rekkefølge i de hvite feltene?
Den grå teksten på siden gir deg noen hint. Skjul teksten om du ikke vil ha hjelp.
Middels
Ordet starter med bokstaven P
En fugleart
Den nest minste uglen i Norge
PERLEUGLE
Vanskelig
Finn alle ordene. Ordene kan stå vannrett, loddrett eller diagonalt, og kan ofte stå skrevet baklengs.
ABORTDEBATT ANATOM BLINDESKRIFT EMANSIPERING JUBELÅR KEISERKRONING LØGNER NARKOTIKALIGA
NEVROLOG PRAKSISÅR ROMHELG SKJEBNEÅR TOSSET UBESLEKTET UPÅKLEDD

PARATS TRENINGSSIDE MED HJERNETRIM
Sender du oss løsningen på alle oppgavene på denne siden, er du med i trekningen av en Elvang Latitude alpakka-pledd av 50 prosent alpakkaull, 40 prosent fåreull og 10 prosent mikrofiber. Pleddet er Fair Tradesertifisert. Målene er 130x200 centimeter (se foto).

Frist for å sende inn løsningen er 3. september 2018. Vi trekker én vinner hver gang. Send løsningen til redaksjonen, enten på e-post til trygve. bergsland@parat.com, eller ordinær post til: Parat, postboks 9029 Grønland, 0133 Oslo. Husk å merke e-posten/konvolutten «Hjernetrim 2/2018». Vinneren av hjernetrim i 1/2018 er Kåre Steinsvik, fra Straume.
En kveld satt jeg og snakket med min sønn på sju år og min datter på elleve, om forskjellige ting.
Det var da jeg stilte dem spørsmålet; vet dere hva en fagforening gjør, hva er Parat?
Det var kanskje litt urettferdig å stille en sju og en elleveåring et slikt spørsmål, og jeg forventet ikke egentlig at de skulle gi meg et utfyllende svar. Det var mest for å få til en prat om temaet. Han på sju svarte at fagforeninger gjør slik at de som jobber får lønnen og ferien sin, mens hun på elleve svarte at Parat også er et blad.
Mine barn er nok noe påvirket av farens jobb. Likevel tror jeg svarene også kan gjenspeile opplevelsen mange av medlemmene i Parat sitter igjen med. For mange av våre medlemmer er Parat i hovedsak bladet som kommer i postboksen. Svært mange av våre medlemmer har problemfrie og trygge jobber, og har sjelden eller aldri behov for å kontakte fagforeningen og få bistand. Parat er tryggheten de har i bakhånd, eller også den som ordner billige forsikringer.
For deg som har lokal tillitsvalgt, er det kanskje det du ville svart på mitt spørsmål; den tillitsvalgte er Parat for meg. Det er nettopp derfor vi satser store deler av organisasjonens ressurser på å ha så mange gode og godt skolerte tillitsvalgte som Parat har. Våre tillitsvalgte er organisasjonens ambassadører. De skal ha de beste forutsetningene for å både rekruttere nye medlemmer, ivareta dem vi har, og representere Parat og medlemmene overfor arbeidsgiver på en god måte når det er nødvendig.
Kanskje er du imidlertid et av de mange fornøyde medlemmene som har fått bistand fra noen av våre om lag 60 kompetente ansatte i vår administrasjon. For dem som har opplevd profesjonaliteten i vårt administrative apparat som ikke bare er en støtte for de tillitsvalgte, men også tilgjengelig for hvert enkelt medlem, blir ofte verdien av Parat veldig synlig.
Våre ansatte løser store og små saker for medlemmer og grupper hver dag hele året. Mange av våre medlemmer har ikke en tillitsvalgt å be om hjelp. For den enkelte er tryggheten i å ha noen å kontakte når sjefen endrer bonusavtalen med tilbakevirkende kraft, når overtidsbetalingen uteblir, eller når du ikke får fast jobb etter fem års vikariat i samme stilling, viktig. For den enkelte er det ingenting som er viktigere enn trygghet i jobben, og hjelp når du trenger det.
Parats mål er å gi trygghet til hver enkelt og bidra til rettferdighet i arbeidslivet, samtidig som vi er med på å skape gode arbeids
plasser. Det norske arbeidslivet er veldig bra. Likevel finnes det helt sikkert noe som kan bli bedre, og jeg tror på at ny teknologi og samarbeid mellom arbeidstaker og arbeidsgiver både vil skape jobber og sikre overgangen til nye jobber for mange av oss.
I Parat har vi vokst til nesten 40 000 medlemmer. Veksten kommer av at vi leverer kvalitet, og at medlemmene vi har er fornøyde og sier det til kolleger og venner.
Nylig kom Personellforbundet med sine om lag 3000 medlemmer inn i Parat og blir en underorganisasjon med navnet «Parat forsvar». De er sivilt ansatte og vervede personell i Forsvaret. Jeg vil gjerne ønske dem alle velkommen, og håper Parat vil bli akkurat det de trenger både som gruppe og enkeltmedlemmer.
For alle våre 40 000 medlemmer må vi levere og være parat. Vi må levere i bladet, vi må levere gjennom den tillitsvalgtes muligheter og ved våre ansattes tilgjengelighet og kompetanse. Akkurat nå i tiden fremover håper jeg imidlertid vi som fagforening kan være noe du tenker på som en bidragsyter til at du forhåpentlig får ta din velfortjente ferie.
God sommer!

Vegard Einan
Nestleder i Parat
Twitter: @vegardeinan
Facebook: facebook.com/ VegardNestlederParat/



Skalljakke for vår og sommer. Vind- og vannavvisende i dame og herrestørrelse 555 kroner *

Hettegenser i økologisk bomull, leveres i dame og herrestørrelse 379 kroner *

T-shirt i økologisk bomull, leveres i dame og herrestørrelse 149 kroner *

Parat har valgt ut et lite utvalg kvalitetsklær. Medlemmer og tillitsvalgte kan bestille klærne i parat.shop.idegroup.no og betaler kun vår innkjøpspris.
Parat betyr at vi alltid står klar, uansett når du trenger hjelp. Et enkelt norsk ord som er tydelig i sitt budskap og som har fått Språkrådets pris for nettopp dette.
Fargen er oransje, som gir varme og som signaliserer glede, bevegelse og nytelse. Oransje virker oppløftende og den jager triste tanker på dør. Oransje stimulerer også til aktivitet, nysgjerrighet og kreativitet.



Har du planer om å leie ut deler av huset eller har du en leilighet for utleie? Da er det smart å sette opp en depositumskonto som sikkerhet for leieforholdet. Nå kan du ordne dette enkelt på nett – verken leietager eller du trenger å møte opp i banken. Les mer på gjensidigebank.no
Har du planer om å leie ut deler av huset eller har du en leilighet for utleie? Da er det smart å sette opp en depositumskonto som sikkerhet for leieforholdet. Nå kan du ordne dette enkelt på nett – verken leietager eller du trenger å møte opp i banken. Les mer på gjensidigebank.no